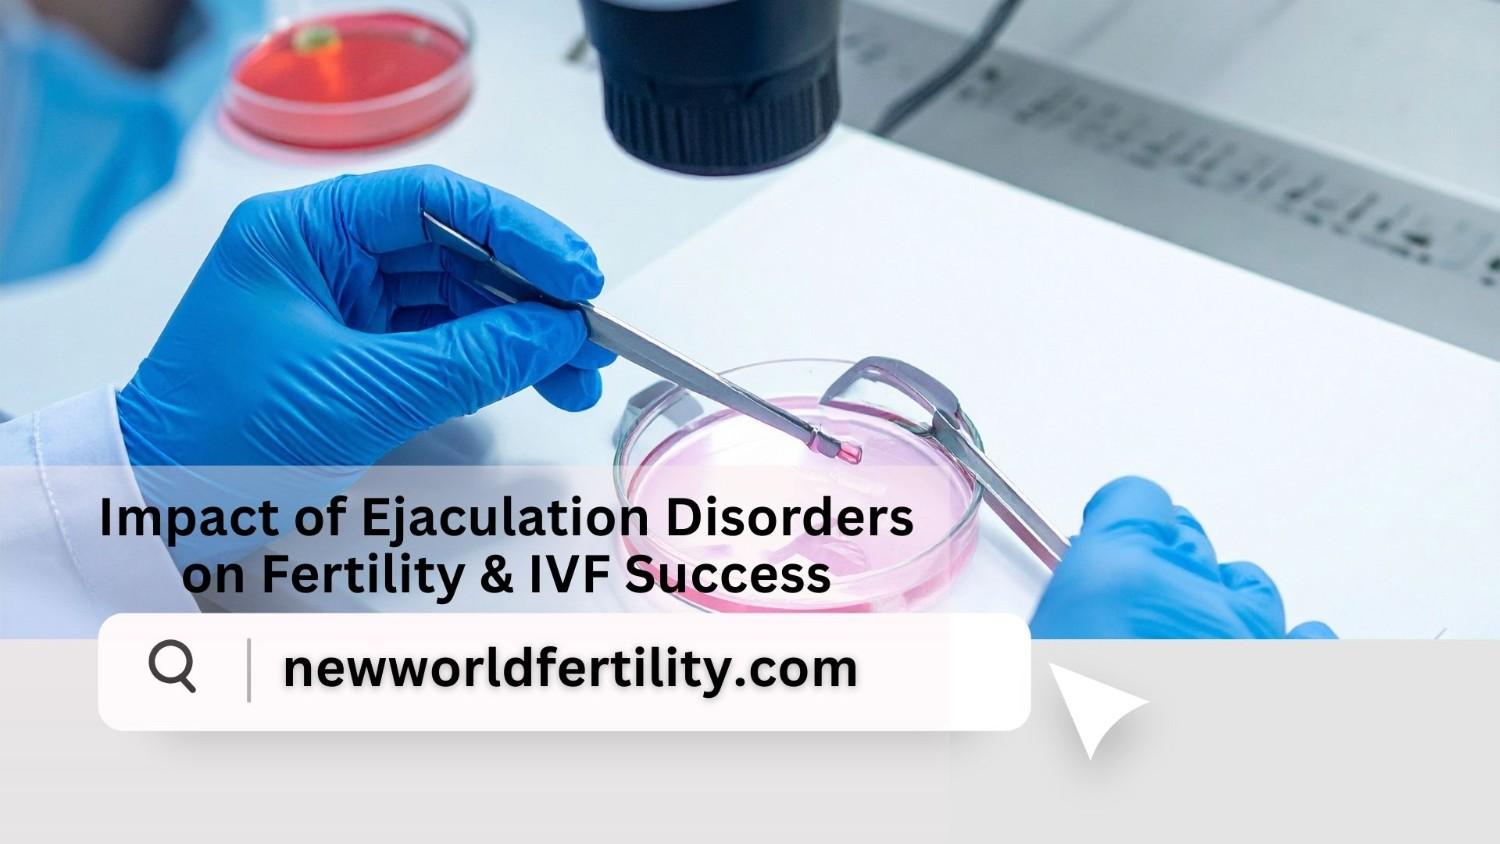

Signs of Successful & Unsuccessful Embryo Transfer | New World Fertility
After an embryo transfer, many women track symptoms, looking for positive signs after embryo transfer or worrying about signs of failed IVF. Early signs of success include implantation spotting, mild cramps, fatigue, and breast tenderness. However, some women experience no symptoms but still have a successful pregnancy. The best way to confirm is a beta hCG test on Day 10-14. If you have concerns, contact New World Fertility for expert guidance.
Read MoreImportance of Laparoscopy in Female Infertility Treatment | New World Fertility
Laparoscopy is a minimally invasive procedure used to diagnose and treat infertility-related conditions like endometriosis, blocked fallopian tubes, and fibroids. It enhances natural conception and increases IVF success rates. With quick recovery and minimal discomfort, laparoscopy is a preferred option for couples facing unexplained infertility. At New World Fertility, we offer advanced laparoscopic treatments to improve fertility outcomes.
Read MoreInspiring Patient Stories & Treatment Success Rates | New World Fertility
Choosing the right fertility center is crucial for success. New World Fertility Center, known as the Best IVF Center in Delhi, offers cutting-edge treatments with high success rates. With IVF success rates up to 70%, personalized care, and advanced technologies like ICSI, IUI, and genetic testing, thousands have realized their dream of parenthood. Read real patient stories and expert insights to understand why New World Fertility Center is a top choice. Book your consultation today!
Read MoreA Complete Guide to Fertility Preservation Procedures & Costs
Fertility preservation helps individuals safeguard their reproductive potential for future family planning. It includes methods like egg freezing, embryo freezing, sperm freezing, ovarian tissue freezing, and testicular tissue freezing. Cancer patients can also benefit from specialized preservation techniques before treatments. At New World Fertility, we offer cutting-edge procedures at affordable costs. Whether due to medical conditions or personal choices, preserving fertility is now easier than ever.
Read MoreEffect of IUI for PCOS: New World Fertility
IUI is a popular fertility treatment for women with PCOS, helping improve conception rates by bypassing common ovulation challenges. With ovulation induction, the success rate ranges from 10-20% per cycle, increasing up to 40-50% after multiple attempts. Factors like BMI, ovulation response, and sperm quality impact success. If IUI fails, IVF may be a better option. At New World Fertility, we provide expert guidance to boost your IUI success.
Read MoreTop Benefits of IVF: Why It’s a Life-Changing Fertility Treatment
IVF at New World Fertility Centre offers high success rates, personalized care, and advanced technology. It addresses various infertility issues and includes genetic screening. Start your journey to parenthood with our expert team.
Read MoreWhat Is Ovarian Stimulation? Process, Benefits & IVF Success Explained
Ovarian stimulation boosts egg production for IVF using hormone medications. At New World Fertility Centre, we closely monitor the process to optimize results and manage side effects.
Read MoreCan Uterine Fibroids Affect IVF Success? Causes, Risks & Solutions Explained
गर्भाशय फाइब्रॉइड्स आईवीएफ की सफलता को प्रभावित कर सकते हैं, खासकर जब ये सबम्यूकोसल होते हैं। ये गर्भाशय की संरचना को बदल सकते हैं, जिससे इम्प्लांटेशन में समस्याएँ हो सकती हैं। न्यू वर्ल्ड फर्टिलिटी सेंटर में विशेषज्ञ फाइब्रॉइड्स का उचित मूल्यांकन और उपचार प्रदान करते हैं।
Read MorePremenstrual Syndrome (PMS): Symptoms, Causes, Treatment & Relief Tips
PMS causes mood swings and bloating before menstruation. New World Fertility Centre in Delhi offers personalized care to manage and relieve symptoms.
Read MorePlanning a Family? Here’s Why Fertility Testing is Essential
Fertility testing at New World Fertility Centre in Delhi identifies reproductive issues early, aiding personalized treatments and informed decisions. Comprehensive tests for men and women increase conception chances, guiding you towards parenthood.
Read MoreWhat’s Affecting Your Fertility? A Complete Breakdown
Blocked fallopian tubes can impact fertility. Symptoms include pelvic pain and difficulty conceiving. Diagnosis is through HSG, SHG, or laparoscopy. Treatments like surgery or IVF are available. New World Fertility Centre provides expert care to help you achieve pregnancy.
Read MoreExploring Natural Ways to Boost Fertility: A Practical Guide
Natural remedies for infertility include a healthy diet, regular exercise, stress management, acupuncture, and herbal supplements. Maintaining a healthy weight, minimizing toxin exposure, and getting enough sleep can also help.
Read MoreA Beginner’s Guide to IVF Medications and Their Role in Treatment
IVF involves hormones for uterine prep, ovarian stimulants, and a trigger shot. Regular monitoring ensures effectiveness. For guidance, contact New World Fertility Centre, Delhi.
Read MoreWorried About Egg Retrieval? Here’s Exactly What Happens During IVF
Egg retrieval at New World Fertility Centre, Delhi, involves stimulating the ovaries, a trigger shot, and a minor procedure to collect eggs. Our advanced technology and expert team ensure the best results. Contact us!
Read More12 Common Fertility Myths Debunked by Experts (Facts vs Reality)
Think you know the truth about fertility? Think again. From age myths to male fertility misunderstandings — we're busting 12 common myths with real facts. Don’t let misinformation delay your dreams of parenthood. Trust expert insights at New World Fertility and take the right step toward your future family today.
Read MorePregnancy After Miscarriage: Chances, Recovery Timeline & What You Must Know
Can You Get Pregnant After a Miscarriage? Yes, you absolutely can. Most women go on to have healthy pregnancies after a miscarriage. With the right care, support, and recovery time—both physically and emotionally—your chances remain strong. At New World Fertility, we help you heal, understand the cause, and prepare your body for a successful next step. Whether it's one loss or multiple, your dream of parenthood is still within reach.
Read MoreTop 7 Lifestyle Changes to Improve IVF Success Rates | New World Fertility Guide 2026
Boost your IVF success in 2025 with simple lifestyle changes! At New World Fertility, we recommend seven key habits—from a fertility-friendly diet and stress management to quality sleep and avoiding toxins—that can improve your chances of conception. Maintaining a healthy weight, quitting smoking, moderating exercise, and staying hydrated also play vital roles. These expert-backed tips help prepare your mind and body for IVF treatment, giving you the best foundation for success. Start making these changes today and take control of your fertility journey with confidence.
Read More7 Ways Cancer Survivors Can Preserve Fertility after chemotherapy
Cancer treatments like chemotherapy can affect fertility, but modern science now offers hope. Through advanced methods such as egg freezing, sperm banking, embryo preservation, and ovarian tissue freezing, cancer survivors can still achieve their dream of parenthood. At New World Fertility, we provide expert, compassionate guidance to help patients preserve fertility before treatment or explore family-building options afterward. With personalized plans, cutting-edge technology, and holistic support, we ensure survivors have a second chance at creating families. Learn how fertility preservation after chemotherapy can protect your future today.
Read More7 Hidden Thyroid Issues That Affect Fertility
Thyroid health plays a bigger role in fertility than most people realize. Both hypothyroidism and hyperthyroidism can disrupt menstrual cycles, ovulation, sperm health, and even increase miscarriage risk. For couples struggling to conceive—or those preparing for IVF—checking thyroid levels is a vital first step. The good news? With proper diagnosis and treatment, thyroid-related infertility can often be reversed, restoring natural fertility or improving IVF success rates. At New World Fertility, we integrate thyroid testing into every fertility plan to give couples the best chance at parenthood. ????
Read MoreHydrosalpinx Explained: Causes, Symptoms & Fertility Risks
What is a hydrosalpinx? It's a blocked fallopian tube filled with fluid. This condition not only stops natural conception but can also cause IVF failure. Why? The toxic fluid can leak into the uterus, preventing a healthy embryo from implanting. Many women have no symptoms besides infertility. But there is hope. Treatment, often surgery to remove or block the tube before an IVF transfer, can restore your chances of success and help you build your family.
Read More9 Shocking Facts About Bilateral Polycystic Ovaries & Fertility
"Bilateral polycystic ovaries" is an ultrasound finding, not always a diagnosis! It's different from PCOS (Polycystic Ovary Syndrome). PCO means your ovaries have many resting follicles, but you may still be fertile. PCOS is a hormonal disorder that causes irregular ovulation. The primary challenge is not having an egg supply, but releasing it. The great news? PCOS is highly treatable, often with lifestyle changes or medication to help you ovulate.
Read More7 Proven Ways to Reduce Prolactin Naturally for Better Fertility
If you are trying to conceive, high prolactin levels could be the hidden reason. Learning how to reduce prolactin naturally can improve fertility in both men and women. Prolactin is a hormone that helps in milk production, but high levels can stop ovulation, reduce sperm production, and disturb hormones.
Read MoreBest IVF Centre in Tilak Nagar, Delhi (2025) | High Success Rate IVF Clinic
Searching for the best IVF centre in Tilak Nagar, Delhi? New World Fertility offers advanced reproductive treatments with high success rates, expert specialists, and personalized care. Our services include IVF, IUI, ICSI, egg freezing, and surrogacy, ensuring the best outcomes for couples facing infertility. With state-of-the-art technology and affordable treatment packages, we make your parenthood dreams come true. Book your consultation with New World Fertility today!
Read MoreHCG Levels by Week: Normal Range Chart After Implantation (2025)
Understanding hCG levels is crucial for tracking pregnancy health, whether naturally conceived or through IVF. This guide covers normal hCG ranges, testing methods, and what low or high levels indicate. Learn how hCG levels progress week by week, their significance in early pregnancy, and when to consult fertility experts at New World Fertility for personalized care.
Read MoreIntrauterine Insemination (IUI) | New World Fertility
IUI involves placing sperm directly into the uterus to boost fertility. It's less invasive than IVF, with success rates of 10-20% per cycle. Ideal for couples with mild fertility issues at New World Fertility Centre, Delhi.
Read Moreट्रांसवेजाइनल अल्ट्रासाउंड क्या होता है | New World Fertility
ट्रांसवैजिनल अल्ट्रासाउंड और बीटा HCG टेस्ट न्यू वर्ल्ड फर्टिलिटी सेंटर में प्रजनन स्वास्थ्य का सटीक मूल्यांकन करते हैं। ट्रांसवैजिनल अल्ट्रासाउंड प्रजनन अंगों की स्पष्ट छवियाँ प्रदान करता है, जबकि बीटा HCG टेस्ट गर्भावस्था की पुष्टि करता है।
Read MoreWhat is the Difference Between IVF and Test Tube Baby?
IVF and test tube baby are the same; both involve fertilizing an egg outside the body and transferring the embryo to the uterus. "IVF" is the medical term, while "test tube baby" is a common phrase.
Read MoreWhen Should You See a Fertility Specialist? | New World Fertility
Struggling to conceive? If it’s been over a year (or six months if over 35), consult a fertility specialist. New World Fertility Centre’s Couple Screening Package helps diagnose issues early.
Read More4 Weeks Pregnant: Understanding Beta-hCG Levels (2025)
At 4 weeks pregnant, tracking beta-hCG levels is crucial to monitor pregnancy progression. This guide covers normal hCG ranges, early pregnancy symptoms, and essential tips for a healthy start. Learn about implantation, hormonal changes, and when to consult a doctor for concerns.
Read Moreशुक्राणु में असामान्यताएं क्या हैं? (Abnormal Sperm) | New World Fertility
शुक्राणु असामान्यता पुरुष प्रजनन क्षमता को प्रभावित कर सकती है, जिससे गर्भधारण में मुश्किल हो सकती है। इसके मुख्य प्रकार ओलिगोस्पर्मिया (शुक्राणु की कम संख्या), एस्थेनोस्पर्मिया (गतिशीलता की कमी), टेरेटोस्पर्मिया (असामान्य आकार), और एजोस्पर्मिया (शुक्राणु की अनुपस्थिति) हैं। इसका कारण हार्मोन असंतुलन, जीवनशैली, या आनुवंशिक समस्याएं हो सकती हैं। वीर्य विश्लेषण और अन्य जाँचों से इसका पता लगाया जाता है। संतुलित आहार, व्यायाम, दवाइयाँ और आधुनिक प्रजनन तकनीकें (IVF, ICSI) इसका समाधान हो सकती हैं। अधिक जानकारी के लिए New World Fertility से संपर्क करें।
Read Moreपीसीओएस (PCOS) के कारण प्रेग्नेंसी में प्रॉब्लम क्यों होती है?
पीसीओएस (पॉलीसिस्टिक ओवरी सिंड्रोम) महिलाओं में हार्मोनल असंतुलन का एक प्रमुख कारण है, जो अंडोत्सर्जन (ओव्यूलेशन) को प्रभावित करता है और गर्भधारण को कठिन बना सकता है। इसमें अनियमित पीरियड्स, वजन बढ़ना, और पुरुष हार्मोन के बढ़े हुए स्तर देखे जाते हैं। यह स्थिति इंसुलिन प्रतिरोध और सिस्ट बनने की संभावना को बढ़ाती है, जिससे प्रजनन क्षमता पर नकारात्मक प्रभाव पड़ता है। समय पर सही इलाज, जीवनशैली में बदलाव और डॉक्टर की सलाह से पीसीओएस को नियंत्रित कर गर्भधारण की संभावना बढ़ाई जा सकती है।
Read MoreEgg Freezing (Oocyte Cryopreservation): Process, Benefits, & Who Should Consider It?
Egg freezing, or oocyte cryopreservation, allows women to preserve their fertility by retrieving, vitrifying, and storing eggs for future IVF use. Ideal for women delaying motherhood, undergoing medical treatments, or with a low ovarian reserve, this procedure offers flexibility and higher success rates in later pregnancies. With advanced egg freezing at New World Fertility, women can take control of their reproductive future. Contact us to explore fertility preservation options today!
Read MoreSigns of Hormonal Imbalance & PCOS | New World Fertility
Hormonal imbalance and PCOS can silently affect a woman’s reproductive health. Symptoms like irregular periods, acne, weight gain, and excess hair growth are often overlooked. These issues can lead to infertility if not addressed early. PCOS, a major hormonal disorder, disrupts ovulation and increases the risk of pregnancy complications. At New World Fertility, we specialise in identifying and treating hormonal issues with personalised care, helping women restore balance and improve fertility naturally or through assisted treatments like IUI or IVF.
Read MoreFrozen Embryo Transfer (FET) vs Fresh IVF Cycle: Which One Is Better for You?
Choosing between a Fresh IVF Cycle and a Frozen Embryo Transfer (FET)? This blog explains the pros, cons, success rates, and who benefits most from each option. FET often offers better hormonal balance and flexibility, while Fresh IVF may suit certain urgent or natural cycles. At New World Fertility, we help you select the best IVF path for a successful pregnancy. Explore the facts, costs, and patient-centered insights in this expert guide.
Read MoreDoes Erectile Dysfunction affect Fertility?
Erectile dysfunction (ED) can affect fertility by preventing ejaculation, reducing sexual frequency, and causing stress. While ED doesn’t directly harm sperm quality, underlying conditions like diabetes or hormonal imbalances might.
Read MoreHow to Procure Vaginal Thrush?
Vaginal thrush is a fungal infection causing itching, discharge, and discomfort. Prevent it with proper hygiene and breathable clothing. Treat it with antifungal medications or remedies under medical guidance.
Read MoreWhy New World Fertility is the Best IVF Centre in Delhi – Success Stories & Results
New World Fertility is recognized as the best IVF centre in Delhi for its exceptional success rates, cutting-edge technology, and compassionate care. With a dedicated team of fertility experts and hundreds of success stories, we offer personalized treatment plans to help you achieve your dream of parenthood. Explore why couples across India trust us on their fertility journey.
Read MoreWhen to see a Gynaecologist : Facts to Know
If you're struggling with fertility issues, see a gynecologist for irregular periods or painful menstruation. If conception fails after a year, consult an IVF specialist.
Read MoreWhat is the HSG Test? Understanding its Procedure, Benefits, and Risks
The HSG test is an X-ray procedure used to check the uterus and fallopian tubes for blockages or abnormalities that may affect fertility. It involves injecting a contrast dye and taking X-ray images.
Read MoreHandling depression during Pregnancy in 2025 | New World Fertility
Depression during pregnancy is common and treatable. Symptoms include sadness, fatigue, and loss of interest. Treatment involves therapy, exercise, healthy eating, and support.
Read Moreएंडोमेट्रियोसिस के लक्षण !
एंडोमेट्रियोसिस एक दर्दनाक स्थिति है जहां गर्भाशय की परत बाहर बढ़ती है। लक्षणों में मासिक धर्म का दर्द और बांझपन शामिल हैं। इलाज में दवाएं, हार्मोनल थेरेपी, और सर्जरी शामिल हैं।
Read MoreHow to Prepare Yourself for IVF in 2025 | New World Fertility
Preparing for IVF involves a balanced diet, prenatal vitamins, managing stress, moderate exercise, and avoiding alcohol and tobacco. Consult your doctor about medications, get adequate sleep, and build a support network.
Read MoreWhat are the Symptoms of Female infertility?
Irregular periods, painful menstruation, excessive hair growth, abnormal discharge, weight changes, chronic pelvic pain, and difficulty conceiving are common infertility symptoms.
Read MoreAltruistic Surrogacy-Its Pros & Cons in 2025
Altruistic surrogacy involves a surrogate carrying a baby for another person without pay, only covering medical costs. It’s ethical and supportive but can have challenges.
Read MoreAre Test Tube babies and IVF the same thing?
Test tube babies and IVF refer to the same process of assisted reproduction. IVF involves fertilizing an egg and sperm in a laboratory, with the resulting embryo implanted in the uterus.
Read MoreTesticular Pain or Swelling guide | New World Fertility
Testicular pain or swelling isn’t something to ignore. Whether it's a dull ache, sudden sharp pain, or unexplained swelling, these symptoms could point to underlying issues—from infections to serious fertility concerns. At New World Fertility, we help men understand the signs, get timely diagnoses, and receive the right treatment to protect both health and reproductive potential.
Read MoreFrom Struggles to heartbeat : Power of IVF Success
In 2025, dreams became reality for hundreds of hopeful parents. At New World Fertility, we help you take that first step toward a positive pregnancy. Because every heartbeat begins with hope.
Read MoreWhat are the signs of Urinary Incontinence? | New World Fertility
Urinary incontinence is the loss of bladder control, causing urine leakage. It affects both men and women, with treatments including bladder training, medication, or surgery.
Read MoreEgg Freezing vs. Embryo Freezing | New World Fertility
Egg freezing and embryo freezing are two fertility preservation methods, each with its own benefits. Egg freezing involves freezing a woman’s eggs at a specific stage, allowing for later fertilization. Embryo freezing, on the other hand, involves fertilizing eggs with sperm before freezing them as embryos. While egg freezing offers more flexibility for future use, embryo freezing is generally considered more successful as embryos have already undergone fertilization. Both methods provide options for women to preserve fertility for future family planning.
Read MoreSperm cramps: पुरुषों में दर्द के कारण, रोकथाम और इलाज | New World Fertility
स्पर्म क्रैम्प्स पुरुषों में स्खलन के दौरान होने वाला दर्द है, जो प्रॉस्टेट समस्याओं, मूत्र मार्ग में रुकावट, या मांसपेशियों की ऐंठन से हो सकता है। सुरक्षित यौन संबंध, नियमित व्यायाम और प्रोस्टेट स्वास्थ्य की जांच से इसे रोका जा सकता है। अगर दर्द लगातार बना रहे, तो विशेषज्ञ से परामर्श लें। अधिक जानकारी और उपचार के लिए New World Fertility से संपर्क करें।
Read More7 Types of Infertility: Causes, Diagnosis & Best Treatments (2025)
Infertility affects many couples, but understanding its types can help in finding the right solution. From primary and secondary infertility to unexplained and immunological infertility, each type has unique causes and treatments. At New World Fertility, we provide expert care and advanced treatments like IVF, IUI, and hormonal therapy. If you're struggling to conceive, consult our specialists today!
Read MorePuberty vs. Adolescence: Key Differences & Changes (2025)
Puberty and adolescence are often confused, but they are distinct stages. Puberty is a biological process triggered by hormones, leading to physical changes like growth spurts and reproductive maturity. Adolescence, on the other hand, is a broader transition from childhood to adulthood, encompassing emotional, cognitive, and social development. While puberty lasts a few years, adolescence can extend into the early 20s. Understanding these differences helps in navigating these critical life phases. For expert guidance on puberty-related concerns, visit New World Fertility.
Read MoreWhat Is IUI? Everything You Need to Know About Intrauterine Insemination
Intrauterine Insemination (IUI) is a simple and effective fertility treatment where healthy sperm is placed directly into a woman’s uterus to increase the chances of fertilization. This non-invasive procedure is ideal for couples facing issues like low sperm count, mild fertility challenges, or unexplained infertility.
Read MoreDonor Eggs IVF: Step-by-Step Guide, Costs & Success Stories
Donor egg IVF is a powerful solution for individuals facing age-related infertility, low ovarian reserve, or genetic concerns. In this process, a donor’s healthy egg is fertilized and transferred to the recipient’s uterus, significantly improving success rates. Fresh or frozen donor eggs can be used, with success rates reaching up to 65%. While costs vary, New World Fertility offers expert guidance for an affordable and seamless journey to parenthood. Read on to explore the process, costs, and inspiring success stories.
Read MoreUterus Didelphys: Causes, Symptoms, Diagnosis & Treatment
Uterus didelphys is a rare congenital condition where a woman has two separate uteri and, in some cases, two cervices. This anomaly occurs due to incomplete fusion of the Müllerian ducts during fetal development. While some women remain asymptomatic, others may experience painful periods, recurrent miscarriages, or pregnancy complications. Diagnosis typically involves ultrasound, MRI, or hysterosalpingography. Treatment depends on symptoms and reproductive goals, including surgical correction, fertility treatments like IVF, or high-risk pregnancy monitoring. At New World Fertility, we offer expert care to help women with uterus didelphys achieve successful pregnancies.
Read MoreMale Infertility: Causes, Symptoms, Treatment Options & Success Stories
Male infertility is a significant factor in conception challenges, affecting nearly 50% of infertility cases. Causes include low sperm count, poor motility, hormonal imbalances, and lifestyle factors. Common symptoms include difficulty conceiving, erectile dysfunction, and testicular pain.
Read MoreFemale Infertility: Causes, Symptoms & Best Treatments (2025)
Female infertility affects many women due to hormonal imbalances, medical conditions, or lifestyle factors. Common symptoms include irregular periods, painful menstruation, and ovulation issues. Diagnosis involves tests like ultrasound, hormone analysis, and HSG. Treatments range from ovulation induction and IUI to IVF and lifestyle changes. Early medical intervention at New World Fertility can improve success rates.
Read MoreFrom Zero to Nine – What Should You Know! | New World Fertility
Pregnancy involves recognizing early symptoms, prenatal care, nutrition, and labor preparation. New World Fertility Centre in Delhi supports you through each step for a healthy journey to parenthood.
Read MoreFertility Nutrition and Lifestyle Tips | New World Fertility
Optimize your path to parenthood with fertility nutrition and lifestyle tips from New World Fertility Centre, Delhi. Expert guidance on diet, exercise, and lifestyle changes supports your journey to achieving parenthood.
Read MoreStep-by-Step Guide to IVF Treatment | New World Fertility
New World Fertility Centre in Delhi offers expert-guided IVF treatment, including consultation, stimulation, egg retrieval, fertilization, and embryo transfer, with high success rates and personalized care.
Read MoreUnderstanding the Cost of an In Vitro Fertilisation (IVF) Cycle in Delhi
The cost of IVF in Delhi ranges between ₹1.3 to ₹2.5 lakhs per cycle, depending on medications, procedures like ICSI, and lab quality. Many clinics exclude essential services—leading to hidden charges. At New World Fertility, we offer transparent pricing, personalized treatment plans, and affordable packages with no surprises. Because your journey to parenthood deserves honesty, care, and clarity. ???? Learn more at newworldfertility.com
Read MoreFertility After 30: Myths, Facts & Smart ways to Boost Your Chances
Is 30 too late to start a family? Not at all — but understanding how fertility changes after 30 can help you plan better. In this blog, we separate myths from facts and give you actionable tips to improve your chances of conception.
Read MoreProgesterone Test in Pregnancy: Levels, Importance & Results
The progesterone test in pregnancy measures hormone levels essential for maintaining a healthy pregnancy. Low progesterone may indicate risks like miscarriage, while high levels support fetal development. Doctors recommend this test to assess pregnancy viability and hormonal balance. Normal progesterone levels vary by trimester and help determine medical interventions if needed. Understanding results can aid in ensuring a safe pregnancy journey.
Read MoreEmbryo Transfer Process & Positive Signs to Expect After IVF
Embryo transfer is a crucial step in IVF, where a fertilized embryo is placed into the uterus. Positive signs of implantation include light spotting, mild cramping, breast tenderness, fatigue, and a missed period. A blood test after 10-14 days confirms pregnancy. Proper rest, medication adherence, and stress management can enhance success. At New World Fertility, expert fertility care ensures the best outcomes for hopeful parents.
Read MoreWhat is the Luteinizing Hormone (LH)? Function, Normal Levels, & How to Increase It
Luteinizing Hormone (LH) plays a vital role in male and female fertility. It triggers ovulation in women and stimulates testosterone production in men. An imbalance in LH can lead to infertility, irregular cycles, or hormonal issues. Understanding normal LH levels in females, luteinizing hormone in males, and ways to increase LH naturally or medically is crucial. At New World Fertility, we provide expert fertility care to regulate LH levels and enhance reproductive health.
Read MoreIs IVF Painful? Breaking Myths, Understanding the Process
Is IVF painful? This infographic breaks down each stage of the IVF process—from hormone injections to embryo transfer—highlighting where discomfort may arise and how to manage it effectively. With expert tips and patient-friendly advice, discover how to reduce pain and anxiety during your fertility journey at New World Fertility.
Read MoreWhat is Laparoscopy? | New World Fertility
Laparoscopy at New World Fertility Centre is a minimally invasive procedure for diagnosing and treating fertility issues, offering precise results with minimal recovery time and disruption.
Read MoreNatural Cycle IVF in Delhi in 2025
This drug-free IVF method uses the body's natural cycle to retrieve and fertilize one egg, offering cost savings and reducing OHSS risk but with potentially lower success rates.
Read MoreMale Fertility & Age: How Ageing Affects Reproductive Health
Male fertility declines with age, affecting sperm quality, testosterone levels, and conception success. DNA fragmentation in older sperm increases miscarriage risks and genetic disorders. Lifestyle changes like a healthy diet, exercise, and avoiding smoking can improve fertility. Assisted reproductive techniques, such as IVF with ICSI, can help overcome age-related issues. If conception is challenging, consult New World Fertility for expert guidance and personalized treatment.
Read MoreRole of Vitamin B12 in Fertility: Importance, Benefits & Impact
Vitamin B12 plays a vital role in fertility for both men and women. It supports egg quality, sperm health, and hormonal balance, increasing conception chances. A deficiency may lead to irregular ovulation, poor sperm motility, and pregnancy risks. Natural sources include meat, fish, dairy, and fortified foods. Those with low B12 levels should consider supplements. Ensuring optimal intake improves reproductive health and boosts fertility. New World Fertility provides expert guidance on fertility nutrition and treatments.
Read MoreIVF Advantages & Disadvantages: Is It the Right Choice for You?
IVF offers hope to couples struggling with infertility, providing high success rates, genetic screening, and the ability to plan pregnancies. However, it also comes with challenges like cost, emotional strain, and potential side effects. Understanding the IVF advantages and disadvantages helps in making an informed decision. At New World Fertility, the Best IVF Center in Delhi, we provide expert fertility solutions to maximize your chances of success. Schedule a consultation today!
Read MoreIVF Injections: Types, Schedule, Side Effects, & Success Tips
IVF injections are essential for stimulating egg production and preparing the body for a successful embryo transfer. These injections include ovarian stimulation drugs (FSH, LH), ovulation suppression (GnRH agonists, antagonists), egg maturation triggers (HCG), and progesterone support. Proper timing, hydration, and stress management can improve their effectiveness. Common side effects include mild pain, bloating, and mood swings. At New World Fertility, we provide expert guidance for administering IVF injections safely and effectively.
Read MoreVaginal Thrush: Causes, Symptoms & Best Treatments
Vaginal thrush is a common yeast infection caused by Candida overgrowth, leading to itching, discharge, and discomfort. Factors like antibiotics, pregnancy, and weak immunity can trigger it. Symptoms include white, cottage cheese-like discharge, burning sensation, and redness. Treatments include antifungal medications (oral or topical), probiotics, and hygiene measures. Preventing thrush involves wearing breathable fabrics, avoiding douching, and maintaining balanced vaginal flora. At New World Fertility, we provide expert guidance for vaginal health and fertility care.
Read MorePremenstrual Dysphoric Disorder (PMDD): Signs & Solutions
Premenstrual Dysphoric Disorder (PMDD) is a severe form of PMS that affects emotional and physical health. Symptoms include mood swings, depression, anxiety, fatigue, and body pain, occurring before menstruation. PMDD is linked to hormonal imbalances, serotonin deficiency, and stress. Diagnosis involves tracking symptoms over multiple cycles. Treatment options include lifestyle changes, SSRIs, hormonal therapy, and natural supplements like calcium and vitamin B6. At New World Fertility, we offer expert guidance to help manage PMDD effectively and improve overall reproductive health.
Read MoreHypospermia: Causes, Symptoms, Treatment, & Its Impact on Male Fertility
Hypospermia is a condition where semen volume is lower than normal, potentially affecting male fertility. Causes range from hormonal imbalances and lifestyle factors to medical conditions and past surgeries. Symptoms include low semen volume, watery consistency, and fertility challenges. Diagnosis involves semen analysis and hormone tests. Treatment options include lifestyle changes, hormone therapy, medications, and advanced fertility treatments like IVF. At New World Fertility, we offer expert guidance to help overcome male infertility.
Read MoreDifference between 3D and 4D sonography: Which one is right for you?
3D sonography offers detailed images for medical assessments, while 4D sonography shows real-time fetal movements. Choose 3D for diagnostics and 4D for bonding experiences.
Read MoreIs Egg Donation Painful? | New World Fertility
Egg donation may involve mild discomfort, particularly during ovarian stimulation and retrieval, but is generally manageable. The retrieval procedure is performed under sedation, minimizing pain.
Read MoreWhat to expect with a Semen Analysis in 2025
A semen analysis at New World Fertility Centre evaluates sperm health to aid in fertility planning, with expert guidance on next steps based on the results.
Read MoreWhat you should know about Molar Pregnancy
A molar pregnancy involves abnormal tissue growth in the uterus, leading to miscarriage. It’s diagnosed via ultrasound and treated with Dilation and Curettage (D&C).
Read MoreEgg Freezing in India: Ideal Age, Cost & Benefits
Thinking about motherhood later? Egg freezing lets you preserve your fertility at its healthiest stage. At New World Fertility, we offer safe, affordable, and advanced egg freezing solutions — so you can plan parenthood on your own terms.
Read MoreSuffering from PCOS? effective treatment with New World Fertility Centre
Struggling with PCOS and infertility? At New World Fertility Centre, Delhi, we offer personalized treatments like lifestyle changes, ovulation induction, IUI, and IVF to help you conceive.
Read MoreNatural cycle vs. Medicated Cycles in IVF
Natural IVF uses minimal medication and retrieves one egg, while medicated IVF uses fertility drugs to produce multiple eggs, increasing success rates.
Read MoreCan a Hernia Cause Male Infertility? | New World Fertility
Hernias, especially inguinal hernias, can impact male fertility by affecting blood flow, testicular function, and sperm production. In some cases, hernia surgery may also lead to complications such as scarring or testicular damage, which can further impact reproductive health. If you're experiencing fertility issues and have a history of hernias, consulting a specialist is crucial. At New World Fertility, we provide expert evaluations and treatment options to help restore fertility. Contact us today to learn more about your reproductive health!
Read MoreHormonal Health and IVF: How Hormones Impact Fertility & Treatment Success
Hormonal health plays a vital role in IVF success, influencing ovulation, egg quality, and implantation. Key hormones like FSH, LH, estrogen, and progesterone must be balanced for optimal fertility outcomes. Imbalances can lead to irregular cycles, poor egg quality, or miscarriage. Adopting a hormone-friendly lifestyle—managing stress, maintaining a healthy diet, and following medical advice—can enhance IVF success. At New World Fertility, we provide expert guidance and personalized treatments to optimize hormonal health for the best chances of conception.
Read MoreNavigating Thyroid disorders treatments for Fertility
Thyroid disorders can affect fertility. New World Fertility Centre in Delhi provides treatments like medication and IVF to manage these issues and improve conception chances.
Read MoreSpotting Early Signs of Low Sperm Count | New World Fertility
Low sperm count can be silent, but recognizing early symptoms is vital for timely intervention. In this blog, we’ll explore the signs of low sperm count, its causes, and steps you can take to improve sperm health.
Read MoreHow Ovary Size Affects Egg Quality and Fertility
Ovaries are small, oval-shaped organs that store and release eggs for fertilization. The average ovary measures between 3 to 5 cm in length, but this size can vary based on age, hormonal health, and individual factors. Generally, a healthy ovary contains a good number of follicles, which are fluid-filled sacs housing immature eggs.
Read MoreTest Tube Baby Centre in Delhi | New World Fertility
New World Fertility Centre in Delhi provides advanced test tube baby (IVF) treatment with high success rates, expert care, and affordable packages, helping couples achieve parenthood.
Read MoreNegative Pregnancy test 14 days after Embryo Transfer
A negative pregnancy test 14 days after embryo transfer usually means the embryo did not implant successfully. Factors like embryo quality and uterine lining can affect results.
Read MoreMissed Period with Negative Pregnancy Test (12 Causes)
A missed period with a negative pregnancy test may be due to stress, hormonal changes, PCOS, thyroid issues, or lifestyle factors. Consult a doctor if the issue continues.
Read MoreKnow the Right Timing of Ovulation (2025)
Ovulation is when an egg is released and is your most fertile period. Track it using calendars, BBT, or OPKs. For help with conception, consult New World Fertility Centre, Delhi.
Read MoreCan IVF Fail Due to Sperm?
Poor sperm quality can affect IVF success rates. At New World Fertility Centre in Delhi, we assess sperm health and offer interventions to improve quality, helping enhance the chances of successful conception.
Read MoreIs it Possible to Build a Career with Motherhood? | 2025 Guide
Balancing a career and motherhood is possible with proper planning and modern fertility options. Women can delay motherhood through egg or embryo freezing and explore treatments like IVF later.
Read MoreHow is Sperm Collected for IVF and IUI Treatments?
Sperm collection for IVF and IUI is typically done through masturbation at a clinic, with alternatives like vibratory stimulation or surgical retrieval if needed.
Read MoreGetting Pregnant with Endometriosis: Is it Possible?
Pregnancy with endometriosis is possible. New World Fertility Centre in Delhi offers treatments like IUI, IVF, and surgery to improve fertility and help women with endometriosis conceive successfully.
Read MoreWhat is Post Ejaculation Urine Analysis (PEUA)?
Post Ejaculation Urine Analysis (PEUA) checks urine for sperm after ejaculation to assess male fertility and diagnose issues like retrograde ejaculation. It’s an important test offered at New World Fertility Centre, Delhi.
Read More10 Self Acupressure Points that Improve Pregnancy Rates in 2025
Acupressure can enhance fertility by improving blood flow, balancing hormones, and reducing stress. Key points like Zigong, SP6, and CV6 support reproductive health and regulate cycles.
Read MoreWhat to Expect During Your Embryo Transfer: 2025 Guide
Embryo transfer is a pivotal step in the journey to parenthood, marking the final phase of the IVF process. Despite its significance, the procedure itself is straightforward, lasting about 10 minutes, and is generally pain-free. During the transfer, your fertility specialist uses a catheter and ultrasound guidance to place the embryo(s) into your uterus. Most patients report only mild cramping.
Read MoreSperm Health and Male Fertility: Tips to Improve Sperm Count and Quality Naturally
Sperm health refers to various factors, including sperm count, motility (movement), and morphology (shape). According to the World Health Organization (WHO), a normal sperm count is at least 15 million sperm per milliliter of semen. Healthy sperm are essential for conception, and factors such as diet, age, and lifestyle choices can impact sperm production and quality.
Read MoreWhy do periods extend long? What may be the probable reasons?
Prolonged menstrual periods, lasting over seven days, can stem from hormonal imbalances, uterine fibroids, endometriosis, or stress. Seek medical help if you experience severe pain or changes in your cycle.
Read MoreWe help Patients become Parents | New World Fertility
New World Fertility Centre in Delhi helps patients achieve parenthood with personalized fertility treatments, including IVF, IUI, and surrogacy, led by a compassionate, expert team.
Read MoreSonosalpingography – SSG Test, Procedure, Cost & Advantages in 2025
Sonosalpingography (SSG) is a safe, non-invasive test to evaluate fallopian tube health and uterine abnormalities, essential for infertility diagnosis.
Read More6 Key Tips for Choosing the Best IVF Specialist in Delhi
Choosing the right IVF specialist in Delhi is crucial for a successful pregnancy. This guide covers essential factors like experience, success rates, and advanced technology to help you make the best decision. New World Fertility offers expert care, transparency, and high success rates, making it a top choice for aspiring parents.
Read MoreHow Obesity Affects Fertility in Females
Obesity can significantly impact a woman’s fertility by disrupting hormonal balance, ovulation, and egg quality. High BMI levels are linked to irregular periods, PCOS, and lower IVF success rates. However, even a small weight loss (5–10%) can improve ovulation and conception chances. At New World Fertility, we offer personalized fertility plans, lifestyle counseling, and advanced treatments to help overweight women conceive successfully. Take the first step toward parenthood with expert support.
Read MoreMale Infertility: Causes, Symptoms & Best Treatments
Male infertility contributes to nearly half of all infertility cases. It’s often caused by low sperm count, poor motility, hormonal issues, or varicocele. Symptoms may include difficulty conceiving, low libido, or testicular discomfort. At New World Fertility, we offer expert diagnosis through semen analysis, hormone testing, and scrotal ultrasound. With customized treatments like IUI, ICSI, or hormone therapy, fatherhood is absolutely possible. Book your confidential consultation today and start your journey toward parenthood.
Read MoreHow High Blood Pressure (Hypertension) Affects Male Fertility 2025
High blood pressure (hypertension) doesn’t just affect heart health—it can also harm male fertility. Poor circulation reduces blood flow to the testicles, leading to lower sperm count, poor motility, and erectile dysfunction. Hypertension may also disrupt testosterone levels, further impacting reproductive health. Some blood pressure medications can worsen fertility issues. At New World Fertility, we offer expert advice and solutions to improve male fertility. Learn how lifestyle changes, diet, and medical treatments can help. Visit us today to take control of your reproductive health!
Read MoreInfertility: Causes, Treatments & Best Solutions for Parenthood
Infertility affects millions worldwide, making conception difficult despite regular unprotected intercourse. It can be caused by hormonal imbalances, ovulation disorders, low sperm count, or blocked fallopian tubes. Common symptoms include irregular periods, low libido, and failure to conceive after a year of trying. Diagnosis involves tests like semen analysis, AMH test, and pelvic ultrasound. Treatments range from medications and lifestyle changes to advanced procedures like IVF, IUI, and ICSI. At New World Fertility, we provide expert care with personalized solutions and high success rates. Contact us today for a consultation!
Read MoreWhat is a Bulky Uterus?
A bulky uterus is an enlarged uterus, often caused by fibroids, adenomyosis, or hormonal imbalances. Common symptoms include heavy bleeding, pelvic pain, and bloating.
Read MoreIs Age a Limiting Factor for Conception in a Women?
A woman’s fertility decreases with age, particularly after 35. New World Fertility Centre offers treatments like IVF and egg freezing to support conception for older women.
Read MoreImpact of Ejaculation Disorders on Fertility & IVF Success
Ejaculation disorders can impact fertility by preventing sperm from reaching the egg. IVF techniques like sperm retrieval and ICSI offer effective solutions for men with ejaculation issues.
Read MoreIVF & IUI: Which Treatment is Right for You?
Deciding between IVF and IUI depends on your fertility issues. IUI is less invasive and suited for mild problems, while IVF is more advanced for severe cases. Consult Now!
Read MoreIVF Success Rates in Delhi: What Couples Should Know Before Starting Treatment
When starting IVF, one of the biggest questions couples ask is: “What is the success rate of IVF in Delhi?” At New World Fertility, we provide clear answers backed by real results. With success rates above the city’s average, our expert fertility specialists, advanced technology, and personalized treatment plans give couples the best chance of parenthood. From counseling to genetic testing and embryo freezing, we offer complete care under one roof. Discover how age, lifestyle, and medical history impact IVF outcomes—and why choosing the right clinic makes all the difference.
Read MoreUnderstanding the IVF Journey: A Step-by-Step Guide
The IVF journey can be emotional yet hopeful. From fertility testing to embryo transfer, each step is carefully designed to increase your chances of pregnancy. This guide explains the IVF process step-by-step, helping you understand what to expect and how to prepare for success. Whether you're just starting or considering your options, knowing the IVF pathway brings clarity and confidence to your parenthood journey.
Read MoreYour IVF Journey Starts Here: Expert Insights from New World Fertility
Struggling to conceive can be emotionally challenging, but New World Fertility, a leading IVF clinic in Delhi, is here to guide you. Our expert fertility specialists provide personalized IVF treatment tailored to your needs, using state-of-the-art technology to ensure high success rates. From initial consultation to emotional support and financial guidance, we make your IVF journey smooth and reassuring. Couples trust us for compassionate care, advanced procedures, and real success stories. Take the first step toward parenthood today—schedule your consultation and start your journey with confidence at Delhi’s most trusted fertility center.
Read MoreIVF Success in Delhi: Your Complete Guide with New World Fertility
Struggling to conceive can be overwhelming, but New World Fertility, a leading IVF clinic in Delhi, is here to support you. Our expert fertility specialists provide advanced IVF treatment tailored to your unique needs, using state-of-the-art technology to maximize success rates. We combine medical expertise with emotional support, counseling, and financial guidance, ensuring a smooth and confident journey. From the first consultation to embryo transfer and follow-up care, every step is handled with precision and compassion. Take the first step toward parenthood—schedule your consultation today and experience Delhi’s most trusted fertility center.
Read More15 Foods and Drinks to eat & avoid during Pregnancy
During pregnancy, prioritize nutritious foods like leafy greens, whole grains, dairy, lean meats, eggs, and fruits. Avoid raw seafood, undercooked eggs, high-mercury fish, alcohol, and unpasteurized dairy.
Read MorePregnancy Heartburn: 7 ways to get Relief | 2025 Guide
Pregnancy heartburn is common but manageable. Eat smaller meals, avoid trigger foods, stay upright after eating, wear loose clothing, and chew gum. For persistent symptoms, consult your doctor.
Read MoreThe vital role of Hysteroscopy in IVF
Hysteroscopy is a vital procedure in IVF that helps identify and treat uterine abnormalities like polyps and fibroids, improving embryo implantation and increasing IVF success rates.
Read MoreWhat causes Menstrual Cramps?
Menstrual cramps can result from uterine contractions or conditions like endometriosis and fibroids. Severe cramps may need medical attention. New World Fertility Centre in Delhi offers expert care for managing menstrual pain.
Read MoreWhat are the Different Treatment Options Available in IVF?
New World Fertility Centre in Delhi offers various IVF treatments, including conventional IVF, Natural Cycle IVF, Mini IVF, ICSI, and more, tailored to individual fertility needs for optimal success.
Read More4 Ways Laparoscopic Surgery can help with Infertility
Laparoscopic surgery at New World Fertility Centre helps treat infertility by addressing conditions like endometriosis, ovarian cysts, and blocked fallopian tubes, enhancing the chances of successful conception.
Read Moreप्रजनन क्षमता बढ़ाने के 16 प्राकृतिक तरीके!
प्रजनन क्षमता को बढ़ाने के लिए संतुलित आहार, नियमित व्यायाम, तनाव प्रबंधन, और पर्याप्त नींद लें। धूम्रपान और शराब से बचें, कैफीन सीमित करें, और विटामिन और नट्स शामिल करें। नियमित जांच और विशेषज्ञ सलाह प्रजनन स्वास्थ्य के लिए महत्वपूर्ण हैं। छोटे बदलाव बड़ा असर डाल सकते हैं!
Read MoreWhat is Infertility: Causes, Symptoms & Treatment
Infertility may stem from various factors. Diagnosis involves tests like semen analysis and ultrasounds. Treatments include medication, IVF, and lifestyle changes.
Read MoreWhich IVF is right for me? | New World Fertility
New World Fertility Centre in Delhi offers IVF options like Traditional IVF, Mini IVF, and ICSI. The best treatment depends on factors like age and fertility issues, with experts helping you choose the right option.
Read MoreZero sperm count? What next?
Zero sperm count (azoospermia) can be treated with options like surgical sperm retrieval, hormonal therapy, or IVF/ICSI at New World Fertility Centre in Delhi. If necessary, sperm donation is also available.
Read MoreThe relationship between Stress and Infertility
Stress can impact fertility by disrupting hormones and ovulation. Managing stress through techniques like meditation and therapy can enhance reproductive health.
Read MoreGestational Carrier – Surrogacy: A Pathway to Parenthood
Gestational surrogacy at New World Fertility Centre helps individuals and couples become parents when they cannot carry a pregnancy, using a surrogate who has no genetic link to the baby.
Read MoreDifference Between Mild IVF and Conventional IVF
Mild IVF uses lower medication doses and retrieves fewer eggs with fewer side effects. Conventional IVF uses higher doses for more eggs. Choose based on your needs and consult New World Fertility Centre
Read MoreWhy Am I Not Getting Pregnant the Second Time?
Struggling to conceive again could be due to age, health changes, or underlying issues. At New World Fertility Centre, we provide expert evaluations and tailored treatments to support your journey. Contact us to explore your options.
Read MoreHow to Treat Hormonal Imbalance?
Hormonal imbalances affect health and fertility. At New World Fertility Centre, we offer tailored treatments, including medications and lifestyle changes, to restore balance. Contact us!
Read MoreHow to Read a Sperm Analysis Report?
At New World Fertility Centre, a sperm analysis assesses semen volume, sperm count, motility, and morphology to diagnose male infertility. Consult our experts to interpret your results and explore treatment options.
Read MoreCan Men Freeze Sperm at Home? Risks and Realities
Thinking of freezing sperm at home? While at-home kits may sound private and convenient, they carry serious risks—poor sample quality, contamination, and transport issues that can damage sperm beyond use. Professional sperm freezing at a fertility clinic is far safer and ensures long-term viability, secure storage, and higher IVF success rates. At New World Fertility, we use advanced cryopreservation technology to protect your fertility with confidence.
Read MoreHow Genetic Testing Is Helping Women Over 35 Conceive Faster
For women over 35, IVF can feel like a race against time due to declining egg quality and higher miscarriage risks. But with genetic testing (PGT-A), the odds are improving. This advanced screening process identifies healthy embryos with the best chance of implantation, reducing failed cycles and offering faster, safer paths to pregnancy. Backed by clinical research, PGT-A has become a game-changer for women in their late 30s and 40s. In this blog, we explain how genetic testing works, its benefits, and why it could be the right step for your IVF journey.
Read MorePreserving Fertility Before Cancer: Egg and Tissue Freezing Options
Facing cancer doesn’t mean giving up on parenthood. At New World Fertility, we help you preserve your fertility before treatment with advanced options like egg freezing, embryo freezing, and ovarian or testicular tissue freezing. Whether you need a fast-track solution or a long-term plan, our expert team ensures safe, compassionate, and personalized care—so your dream of a family stays alive. With cutting-edge technology and dedicated support, you can focus on recovery while safeguarding your future. ????
Read MoreWhat is intracytoplasmic sperm injection (ICSI)? | New World Fertility
ICSI at New World Fertility Centre, Delhi: Advanced IVF technique injecting sperm directly into eggs, ideal for severe male infertility. Customized treatment plans and expert care maximize success rates for couples seeking parenthood.
Read MoreThe Truth About Andropause (Male Menopause)
Andropause, or male menopause, involves reduced testosterone, causing fatigue and mood changes. It’s managed with lifestyle adjustments and hormone therapy. Contact us!
Read MoreDoes Egg Freezing Affect Natural Fertility?
एग फ्रीजिंग से प्राकृतिक प्रजनन क्षमता पर कोई नकारात्मक प्रभाव नहीं पड़ता है। यह प्रक्रिया अंडाणुओं को सुरक्षित करती है, न कि आपकी प्रजनन प्रणाली को। हार्मोनल उपचार अस्थायी प्रभाव डाल सकता है, लेकिन दीर्घकालिक स्वास्थ्य पर कोई असर नहीं होता।
Read MoreUterine Factor Infertility: Causes, Symptoms, Diagnosis, & Best Treatment Options
Uterine factor infertility occurs when abnormalities in the uterus prevent pregnancy. Symptoms include recurrent miscarriages, irregular menstruation, and pelvic pain. Causes range from congenital anomalies to fibroids and uterine scarring. Diagnosis involves ultrasounds, hysteroscopy, and MRI. Treatment options include surgical correction, IVF, surrogacy, and emerging uterus transplants. New World Fertility offers expert solutions for overcoming uterine infertility and achieving parenthood.
Read MoreAMH Test: About Fertility, Levels, and Treatment Options
The AMH test is a key fertility assessment that measures ovarian reserve. It helps predict IVF success, diagnose PCOS, and plan fertility treatments. The AMH test cost in Delhi ranges from ₹1,500 to ₹4,000. For low AMH treatment, options include supplements, lifestyle changes, IVF, and egg donation. If you're looking for the best fertility solutions, consult New World Fertility for expert guidance.
Read MoreEgg Freezing: 10 Essential Things to Consider Before Preserving Your Fertility
Egg freezing is a smart choice for women looking to preserve fertility, but timing, cost, and success rates matter. The ideal age is before 35, ensuring higher-quality eggs. The process includes ovarian stimulation, retrieval, and vitrification. While success rates vary, freezing 15-20 eggs increases the chances of pregnancy. Consider costs, potential risks like OHSS, and choosing a top fertility clinic. New World Fertility, the Best IVF Center in India, offers expert guidance.
Read MoreDoes Female Masturbation Affect Fertility? Myths, Facts & Expert Insights
Does female masturbation impact fertility? The answer is no! Myths suggest it affects egg count or hormones, but science says otherwise. Masturbation is a normal part of sexual health and has no effect on ovulation or conception. However, factors like stress, age, and medical conditions influence fertility. If you're struggling to conceive, consult New World Fertility, recognized as the Best IVF Center in India for expert fertility solutions.
Read MorePCOS/PCOD Treatment: A Path to Better Health and Fertility
Discover effective treatments for PCOS/PCOD to manage symptoms, improve fertility, and enhance overall well-being. Expert advice from the Best IVF Centre In Delhi New World Fertility.
Read MoreTest Tube Baby in IVF | New World Fertility
A "test tube baby" is a colloquial term for a baby conceived through IVF. Despite the name, the process doesn’t involve babies being grown in test tubes. Instead, it refers to fertilizing an egg with sperm outside the human body in a controlled laboratory environment. The fertilized egg, or embryo, is then transferred into the woman’s uterus to develop naturally, like any other pregnancy.
Read MoreIUI Treatment: Success Rates, Procedure, Costs & Everything You Need to Know
In this comprehensive guide, we will explore the IUI treatment procedure, success rates, costs, and other critical factors that can influence your decision. If you're considering IUI for fertility treatment, read on for everything you need to know!
Read MorePeriods After Pregnancy: What to Expect, Common Changes, and When to Seek Help
Periods after pregnancy often return at different times for every woman—sometimes as early as 6 weeks, or delayed up to a year if breastfeeding. While some women experience heavier flow, irregular cycles, or stronger cramps, these changes are usually part of your body’s recovery. However, very heavy bleeding, persistent irregularity, or no periods for over a year (if not breastfeeding) may signal underlying hormonal issues. At New World Fertility, we help women navigate postpartum health and protect their fertility for the future.
Read MoreWhat Is Vaginismus? Causes, Symptoms, and Treatment Options Explained by Experts
Vaginismus causes painful or impossible penetration due to involuntary vaginal muscle tightening. At New World Fertility, we explain its causes, symptoms, emotional impact, and the latest treatment options. Reclaim intimacy and fertility—help is available and recovery is real.
Read MoreIrritable Bowel Syndrome (IBS): Symptoms, Causes, and Effective Management Strategies
Irritable Bowel Syndrome (IBS) is a common digestive disorder causing abdominal pain, bloating, and unpredictable bowel habits. While not life-threatening, IBS can affect daily comfort, emotional well-being, and even fertility. At New World Fertility, we share expert strategies to manage IBS and improve your quality of life.
Read MoreWhy is Infertility so common Today?
Infertility is rising due to delayed parenthood, lifestyle choices, and environmental factors. New World Fertility Centre, Delhi, offers advanced treatments to help couples achieve their parenting goals.
Read MoreWhat lifestyle changes should be made before starting IVF?
Before IVF, focus on a healthy lifestyle: maintain a balanced weight, quit smoking, reduce alcohol, manage stress, eat well, exercise moderately, and get enough sleep for better IVF outcomes.
Read MoreHow to Improve Egg Quality for IVF & Pregnancy
Improving egg quality is essential for successful IVF and pregnancy. Key strategies include a balanced diet rich in antioxidants, maintaining a healthy weight, reducing stress, and limiting toxins.
Read MoreWhen should you see a Gynecologist?
See a gynecologist for regular check-ups, irregular periods, pelvic pain, or fertility concerns. Early care ensures better health. Book at New World Fertility Centre, Delhi.
Read MoreBicornuate Uterus: Causes, Symptoms and Treatment
A bicornuate uterus, with two cavities instead of one, can cause menstrual irregularities and fertility issues. It’s diagnosed with ultrasound or MRI and may need surgery or fertility treatments.
Read MoreIVF Injections; How Many Injections Are Required?
IVF injections increase egg production, usually given daily for 8-12 days. Patients may need 20-30 injections, adjusted based on individual response and ovarian reserve.
Read MoreWhat is an Embryologist ? | What is the role of Embryologist in IVF
An embryologist is essential in IVF, managing embryo development and enhancing success rates. At New World Fertility Centre in Delhi, expert embryologists provide advanced fertility care and personalized treatment.
Read MoreTubal Evaluation and its process
Tubal evaluation checks fallopian tubes for blockages or damage, vital for diagnosing infertility. New World Fertility Centre offers advanced, affordable testing to support successful pregnancies.
Read MoreEndometrial Receptivity Analysis (ERA) 2025 Guide
Endometrial Receptivity Analysis at New World Fertility Centre enhances IVF success by assessing the uterine lining for optimal embryo transfer timing. This quick, painless test helps improve implantation rates.
Read MoreICSI vs. IMSI: A Comparative Analysis in 2025
ICSI and IMSI are fertility treatments. ICSI involves sperm injection into the egg; IMSI selects higher-quality sperm under magnification for potentially better results.
Read MoreImportant Questions you must ask on your 1st IVF Consultation
At New World Fertility Centre in Delhi, Dr. Apoorva Mishra answers common IVF-related questions, covering topics like required tests, treatment timelines, success rates, and potential side effects.
Read MorePreparing for Labor and Delivery: What you need to know ?
Preparing for labor involves understanding early signs, creating a flexible birth plan, and packing essentials. Explore pain relief options, prepare emotionally, and consider prenatal classes for support.
Read MoreHow Age Impacts Fertility | New World Fertility
Fertility is one of those topics surrounded by a mix of science and speculation. While many of us have heard about the "biological clock," there are still countless myths and misunderstandings about how age truly impacts fertility. This article dives into the facts, dispels myths, and provides a clear, research-based understanding of the connection between age and fertility.
Read MoreWhat is the connection between Celiac disease and Infertility?
Celiac disease can impact fertility due to nutritional deficiencies. Women may face irregular cycles, and men may have lower sperm quality. A gluten-free diet can enhance reproductive health.
Read Moreक्या आईवीएफ प्रक्रिया के दौरान दर्द होता है?
आईवीएफ प्रक्रिया में हल्का दर्द या असुविधा हो सकता है, खासकर अंडाशय उत्तेजना और अंडाणु संग्रहण के समय। यह आमतौर पर अस्थायी होता है और दर्द को दवाइयों और आराम से कम किया जा सकता है।
Read MoreEndometrial Biopsy for Infertility Treatment
An endometrial biopsy examines the uterine lining to diagnose issues affecting fertility. It helps identify abnormalities, guiding treatment for better fertility outcomes.
Read MoreCan I get pregnant with Hypopituitarism?
Yes, pregnancy is possible with hypopituitarism. Treatments like hormone therapy and IVF can help. New World Fertility Centre offers specialized care to support your journey to parenthood.
Read MoreTubal Surgery or IVF which one will be best in 2025
Tubal surgery fixes blocked fallopian tubes; IVF bypasses them for higher success rates. Choose based on your fertility needs. Consult New World Fertility Centre for expert advice.
Read MoreAn Overview of the Surrogacy Process in 2025
Altruistic surrogacy at New World Fertility Centre, Delhi, involves a surrogate carrying a baby without financial gain, following ethical practices and legal guidelines to help couples achieve parenthood compassionately.
Read Moreआईयूआई उपचार के बारे में 9 महत्वपूर्ण तथ्य जो आपको जानना चाहिए।
आईयूआई (इन्ट्रायूटेराइन इंसेमिनेशन) में शुक्राणु सीधे गर्भाशय में डाले जाते हैं, जो गर्भधारण की संभावना बढ़ाता है। यह कम-इनवेसिव प्रक्रिया है और आमतौर पर 10-20% सफलता दर के साथ होती है।
Read MoreAsthenoteratozoospermia Treatment: What Are the Options, Causes & Symptoms?
Asthenoteratozoospermia involves poor sperm motility and abnormal shape. Treatments at New World Fertility Centre include lifestyle changes, medications, and ART. Contact us!
Read MoreUrinary Tract Infection, its Precautions and Cure in 2025
UTIs cause discomfort during urination and frequent urges. Prevent with proper hygiene and hydration. Treatment includes antibiotics and pain relief.
Read MoreWhat is a Uterine Prolapse 2025 guide
Uterine prolapse is when the uterus slips into the vaginal canal due to weakened pelvic muscles. Symptoms include pelvic pressure and urinary issues. Treatment options vary.
Read Moreआईवीएफ के माध्यम से जुड़वाँ बच्चे होने की क्या संभावनाएँ हैं?
आईवीएफ में जुड़वाँ बच्चे होने की संभावना उस पर निर्भर करती है कि कितने एम्ब्रायो प्रत्यारोपित किए जाते हैं। अधिक एम्ब्रायो ट्रांसफर करने से जुड़वाँ बच्चों की संभावना बढ़ सकती है, लेकिन इससे स्वास्थ्य जोखिम भी बढ़ सकते हैं। सही सलाह के लिए New World Fertility Centre से संपर्क करें।
Read MoreDoes certain medications affect fertility?
Medications like NSAIDs and antidepressants can affect female fertility, while anabolic steroids and antihypertensives may reduce male fertility. Consult your doctor about medication effects when trying to conceive.
Read MoreHow to make pregnancy easy while working in 2025
प्रेग्नेंसी के दौरान ऑफिस मैनेज करने के लिए आरामदायक बैठना, ब्रेक लेना, स्वस्थ भोजन करना और समय का सही प्रबंधन जरूरी है। इससे तनाव कम होता है और संतुलन बना रहता है।
Read MoreUrinary Tract Infection (UTI) full guide 2025
UTIs are common and may affect fertility treatments. New World Fertility Centre, Delhi, provides expert care to treat and prevent infections, ensuring they don’t impact your fertility journey.
Read MoreWhat are Tubectomy and Tubectomy Reversal?
Tubectomy is a permanent contraceptive procedure that blocks fallopian tubes. Tubectomy reversal restores fertility but varies in success based on individual factors.
Read MoreHow long does IVF Treatment take? 2025 Guide
IVF treatment usually takes 4-6 weeks, including ovarian stimulation, egg retrieval, fertilization, and embryo transfer, followed by a two-week wait for pregnancy results. Timelines vary by individual.
Read MoreHow much Sperm is enough for Pregnancy?
A healthy sperm count (15 million/mL or more) boosts pregnancy chances, but motility and morphology also matter. Factors like lifestyle, diet, and stress impact sperm health.
Read MoreWhat is assisted reproductive techniques? 2025 Guide
Assisted Reproductive Techniques (ART), such as IVF and ICSI, help individuals and couples conceive. New World Fertility Centre in Delhi provides personalized support for those facing infertility challenges.
Read MoreBenefits of Folic Acid in Pregnancy
Folic acid is vital during pregnancy, aiding fetal growth, preventing neural tube defects, and reducing birth defect risks. It supports cell growth, placenta health, and maternal well-being.
Read MoreThe Best Altruistic Surrogacy Center in Delhi | Newworldfertility
Looking for the best altruistic surrogacy center in Delhi? New World Fertility offers ethical, compassionate, and expert care to help you build your family. Our team ensures a transparent process, personalized support, and world-class medical care for both intended parents and surrogate mothers. Choose us for a smooth, ethical, and fulfilling surrogacy journey.
Read MoreThe Invisible Link Between Air Pollution and Reproductive Health
Air pollution has become a significant concern globally, with its adverse effects on health well-documented. While most people are aware of its impact on respiratory and cardiovascular health, fewer recognize its hidden impact on fertility. Recent research highlights how air pollution can affect both male and female reproductive health, leading to challenges in conception and pregnancy.
Read MoreIUI Pregnancy: What it is & Reasons for Opting
IUI is a fertility treatment where sperm is directly inserted into the uterus to enhance pregnancy chances. It’s ideal for couples with infertility, mild male fertility issues, or ovulation disorders.
Read MoreUterine Fibroids and Fertility: Causes, Symptoms, Diagnosis & Treatment at New World Fertility
Uterine fibroids can impact your ability to conceive. At New World Fertility, we provide expert diagnosis and treatment to help you achieve a healthy pregnancy.
Read MoreStress and Infertility: Understanding the relation between the two
Stress can impact fertility by disrupting hormones, ovulation, and sperm quality, while infertility itself increases stress. Breaking this cycle with relaxation, counseling, and lifestyle changes can improve outcomes.
Read MoreAndrology Services Explained: Diagnosis, Treatment & Male Fertility Solutions
Male infertility is treatable—don’t ignore the signs. At New World Fertility, our advanced andrology services help diagnose and treat male fertility issues with precision and care. From semen analysis to surgical sperm retrieval, we offer complete solutions under one roof.
Read MoreFirst month Pregnancy Food Chart | 2025 Guide
Eat a balanced diet rich in folic acid, protein, calcium, and fiber during the first month of pregnancy. Include leafy greens, fruits, dairy, and whole grains. Avoid raw foods, caffeine, and processed items.
Read MoreEmotional Well Being and Infertility | New World Fertility
Infertility affects emotional well-being, causing stress, anxiety, and isolation. At New World Fertility Centre, we prioritize mental health alongside medical care.
Read MorePGS Technique helps to attain Parenthood after the age of 35
PGS (Preimplantation Genetic Screening) helps women over 35 improve IVF success by selecting healthy embryos, reducing miscarriage risks, and increasing the chances of a healthy pregnancy.
Read MoreWhat is a Mini IVF Treatment? | 2025 Guide
Mini IVF uses lower doses of fertility drugs to produce fewer, high-quality eggs, making it a less invasive, affordable alternative to traditional IVF with reduced risks and side effects.
Read MoreIf your IVF is Failing Again and Again | Full Guide IVF
Repeated IVF failures can be tough. Key factors include age and embryo quality. Consult a fertility specialist, consider lifestyle changes, and explore options like donor eggs or surrogacy for support.
Read MoreDoes intermittent fasting (IF) affect fertility in women?
Intermittent fasting can impact fertility by improving insulin sensitivity and weight loss, but extreme fasting may disrupt hormones and menstrual cycles.
Read MoreHysteroscopy Treatment: step by step guide 2025
Hysteroscopy is a minimally invasive procedure to diagnose and treat uterine issues like fibroids, polyps, and adhesions. It enhances fertility and relieves symptoms like abnormal bleeding. With quick recovery and high success rates, hysteroscopy is a safe and effective solution for
Read MoreImpact of Age on Female Fertility
Age significantly impacts female fertility, with egg quantity and quality declining after 30 and sharply after 35. Women in their 40s face reduced natural conception chances and increased pregnancy risks.
Read MoreIs Annual Gynecological Assessment Necessary for Females?
Annual gynecological assessments help detect and prevent reproductive health issues like cervical cancer, fertility problems, and hormonal imbalances.
Read Moreपीसीओएस और प्रजनन क्षमता: प्रभावी प्रबंधन के व्यावहारिक उपाय
पीसीओएस एक हार्मोनल विकार है जो मासिक धर्म चक्र को प्रभावित कर अंडोत्सर्जन में बाधा डालता है, जिससे गर्भधारण में कठिनाई होती है। New World Fertility में, हम व्यक्तिगत और समग्र दृष्टिकोण अपनाते हुए, संतुलित आहार, नियमित व्यायाम, तनाव प्रबंधन और प्रभावी दवा विकल्प प्रदान करते हैं। हमारी विशेषज्ञ टीम आपके लिए उचित उपचार, क्लोमिफेन, मेटफॉर्मिन, लेट्रोज़ोल और IVF जैसी सहायक प्रजनन प्रौद्योगिकियाँ सुनिश्चित करती है। हमारे संसाधनों के साथ, आप अपनी प्रजनन क्षमता को सुदृढ़ कर एक स्वस्थ भविष्य की ओर बढ़ सकती हैं।
Read MoreFactors that Elevate the Risks of Endometriosis (2025 guide)
Endometriosis risk factors include genetics, early menstruation, high estrogen, and certain lifestyle choices. New World Fertility Centre provides expert care and treatments to manage symptoms and improve fertility outcomes.
Read MoreHow much does it Cost to get an IVF Treatment in 2025?
IVF in Delhi costs ₹1,20,000–₹2,50,000 per cycle. New World Fertility Centre offers affordable pricing, flexible EMI options, and high success rates with no hidden charges.
Read MoreMost Affordable Surrogacy Services in India | New World Fertility
New World Fertility Centre offers affordable and ethical surrogacy services in India, providing comprehensive medical and legal support for intended parents.
Read MoreAssisted Hatching how its works in 2025| New World Fertility
Assisted hatching is an advanced IVF technique where a small opening is made in the embryo’s outer shell (zona pellucida) to improve implantation. It is beneficial for women over 35, patients with repeated IVF failures, frozen embryos, and those with poor embryo quality. At New World Fertility, we specialize in laser-assisted hatching, a precise and effective method to enhance your chances of pregnancy. Contact us today to explore personalized fertility treatments tailored to your needs.
Read MoreUterine Evaluation Treatment in 2025
The uterus is where a fertilized egg implants and develops into a baby. Any abnormalities in the uterine structure or function can hinder this process, leading to infertility or recurrent miscarriages. Studies show that uterine abnormalities contribute to approximately 10-15% of infertility cases. Evaluating the uterus thoroughly helps identify potential issues and paves the way for targeted treatments.
Read MoreHow Strength Training Affects Fertility (2025 guide)
Strength training positively impacts fertility by improving hormonal balance, managing weight, and reducing stress. However, excessive training can disrupt cycles or lower sperm quality.
Read MoreWhat is Pelvic Inflammatory Disease and how to treat it?
Pelvic Inflammatory Disease (PID) is an infection of the female reproductive organs, often caused by untreated STIs. It can lead to infertility, chronic pain, and ectopic pregnancy if untreated.
Read MoreAir Pollution may be associated with increased Risk of Miscarriage
Explore the potential link between air pollution and increased miscarriage risk. This blog discusses how pollutants can affect reproductive health, highlights key findings, and offers practical tips for minimizing exposure.
Read MoreHow can we improve Female Fertility naturally | New World Fertility
Boosting female fertility naturally involves a balanced diet, maintaining a healthy weight, managing stress, staying hydrated, limiting caffeine and alcohol, and getting quality sleep.
Read MoreWhat is Importance of Fertility Awareness in 2025
Fertility awareness aids in conception, early health issue detection, and effective family planning. New World Fertility Centre in Delhi offers expert support to help you manage your reproductive health.
Read MoreMicro TESE: Procedure, Success Rates, Cost & Best Treatment Options
Micro TESE (Microsurgical Testicular Sperm Extraction) is a specialized procedure for men with non-obstructive azoospermia, helping retrieve sperm for IVF/ICSI. Unlike traditional TESE, it uses a high-powered microscope for precise extraction, minimizing tissue damage. The sperm retrieval rate ranges from 40-60%, improving fertility chances. The cost varies, from ₹1,50,000 in India to $10,000 in the USA. Recovery takes 2-3 days, with minimal risks. If you have failed TESE attempts, Micro TESE offers renewed hope.
Read MoreStruggling to Conceive? Top 10 Fertility Mistakes Couples Make Without Realizing
Many couples unknowingly hinder their chances of conception. Discover the top 10 silent mistakes affecting fertility and how to fix them, from timing issues to lifestyle habits.
Read MorePreparing for IVF Mentally & Physically: A 360° Guide to Boost Your Success Rate
Preparing your body and mind for IVF can make a real difference in your success rate. At New World Fertility, we offer a complete guide to help you get ready - physically, emotionally, and nutritionally. From the right supplements and lifestyle changes to stress management and partner communication, every step matters. Whether you're about to start IVF or exploring fertility preservation through egg freezing, this blog gives you the tools to take control of your journey. Read now and give yourself the best chance at parenthood in 2025.
Read MoreTop 10 Causes of Infertility in Men and Women: Symptoms, Diagnosis & Proven Treatments
Infertility can affect both men and women due to hormonal issues, lifestyle habits, or medical conditions like PCOS, low sperm count, or endometriosis. Early diagnosis and timely treatment—like IUI, IVF, or ICSI—can significantly improve your chances of parenthood. At New World Fertility, we provide expert diagnosis, personalised treatment, and emotional support every step of the way. Take the first step today. Parenthood begins with hope.
Read MoreAMH Levels and Fertility: What Every Woman Needs to Know Before Starting IVF
Worried about your AMH levels before IVF? AMH (Anti-Müllerian Hormone) reveals your ovarian reserve—an important step in understanding your fertility. Whether your levels are low or high, the right diagnosis and a personalized IVF plan can lead to success. At New World Fertility, we specialize in IVF for low AMH, offering advanced protocols and compassionate care to help you conceive confidently.
Read MorePrimary and Secondary Infertility: Understanding the Differences & Finding Hope
Struggling to conceive for the first time is called primary infertility. Facing difficulties after having a child? That’s secondary infertility—and it’s more common than you think. Both are emotionally and physically challenging, but the good news is: they’re treatable. At New World Fertility, we help you understand the root cause and guide you toward the right solution—be it IUI, IVF, or lifestyle changes. ???? Your path to parenthood doesn’t end here—it just needs expert guidance. ???? Learn more at newworldfertility.com
Read MoreJourney of a Sperm Cell: From Creation to Conception
From creation in the testes to fertilization in the fallopian tube, a sperm cell’s journey is a high-stakes race for life. Out of millions, only one completes the mission—creating new life. At New World Fertility, we help every sperm count. Whether it’s boosting male fertility or guiding conception, we’re with you every step of the way. ???? Learn more at newworldfertility.com
Read MoreHow Smoking Affects Male & Female Fertility | New World Fertility
Smoking is a major hidden factor that harms fertility in both men and women. For men, it lowers sperm count, reduces motility, and causes DNA damage, making conception harder. For women, smoking accelerates egg loss, damages egg quality, disrupts hormones, and harms reproductive organs, reducing the chances of pregnancy.
Read MoreWhat Are the Common Symptoms of Endometriosis?
Endometriosis isn't just painful periods — it's a silent struggle affecting 1 in 10 women. Common symptoms include pelvic pain, heavy periods, fatigue, pain during sex or urination, and infertility. Early diagnosis is key to protecting your fertility and quality of life.
Read MoreTop 10 Semen Retention Benefits for Health | New World Fertility
Semen retention is gaining momentum in 2025 as more men explore natural ways to enhance physical and mental health. Backed by both ancient wisdom and modern testimonials, this practice offers powerful benefits—from increased testosterone and energy to sharper focus, improved sleep, and emotional resilience. Many report healthier skin, boosted immunity, and deeper relationships as well. While research is still evolving, user stories and early data highlight positive changes in mood, motivation, and overall well-being. When practiced mindfully and in combination with healthy habits, semen retention may help unlock new levels of personal vitality and self-control. Whether you’re looking to improve your fitness, mental clarity, or spiritual depth, this practice offers a holistic approach to male wellness.
Read MoreLow Testosterone in Women: Signs, Causes, Treatment & How It Affects Fertility
Low testosterone in women often goes unnoticed, yet it impacts mood, energy, and fertility. Learn signs, causes, treatments & how New World Fertility can help.
Read MoreIs IUI Process Painful | New World Fertility
IUI is a quick, minimally invasive fertility treatment with little to no pain. New World Fertility Centre ensures a comfortable and expert-guided experience.
Read MoreWhat is IVF Therapy? Its types and benefits
IVF, or In-Vitro Fertilization, is a fertility treatment where eggs and sperm are combined in a lab to create embryos, which are then transferred to the uterus.
Read MoreSemen Analysis: A Diagnostic Tool for Male Fertility
Semen analysis is a simple and non-invasive test that evaluates the quality and quantity of sperm in a man's semen. The test provides valuable insights into male reproductive health and helps diagnose any underlying conditions affecting fertility.
Read MoreTESA: A Breakthrough in Male Fertility Treatment
TESA (Testicular Sperm Aspiration) is a minimally invasive fertility treatment used to retrieve sperm directly from the testicles in men with azoospermia. It plays a crucial role in male infertility care, especially when paired with ICSI in IVF cycles.
Read Moreक्या बार-बार होने वाले गर्भपात में आईवीएफ उपचार मदद कर सकता है?
आईवीएफ बार-बार गर्भपात की समस्या में मदद कर सकता है। यह भ्रूण की जीन जांच, हार्मोनल असंतुलन को सुधारने, और सही भ्रूण स्थानांतरण के माध्यम से गर्भधारण की संभावना बढ़ाता है। New World Fertility Centre से संपर्क करें।
Read MoreThe Role of Weight in Female Fertility: How Body Mass Affects Reproductive Health
Hormonal balance is crucial for fertility. Hormones control everything from the release of eggs during ovulation to the thickening of the uterine lining for pregnancy. Too much or too little fat in the body can affect hormone levels, which can disrupt the natural fertility process.
Read MoreExpert tips to Increase Fertility : Expert Tips for Men & Women
Struggling to conceive? Improve your fertility naturally with expert-backed tips. Maintain a healthy diet, manage stress, track ovulation, quit smoking, and get enough sleep to enhance reproductive health. Essential vitamins, hydration, and avoiding excessive caffeine can also boost fertility. If natural methods don’t work, New World Fertility offers advanced fertility treatments like IVF and IUI. Take control of your fertility today—schedule a consultation with our experts!
Read More12 Natural and Effective ways to stop Nausea Fast in 2025
Nausea can be uncomfortable, but natural remedies offer quick relief. Try ginger tea, peppermint oil, lemon slices, and staying hydrated. Acupressure, cold compresses, and bland foods like crackers also help.
Read MoreUrinary Incontinence – Causes and Treatment | New World Fertility
Urinary incontinence is the unintentional leakage of urine. New World Fertility Centre in Delhi offers treatments like exercises, medication, and surgery to manage it effectively.
Read MoreWhat is the Difference Between Infertility and Impotence?
Infertility is difficulty conceiving, while impotence (erectile dysfunction) is trouble maintaining an erection. Infertility relates to reproductive issues, while impotence affects sexual function.
Read MoreBest IVF Centre in Muzaffarnagar
For the best IVF centre near Muzaffarnagar, choose New World Fertility Centre in Delhi. Led by Dr. Apoorva Mishra, it offers advanced technology, personalized care, and high success rates. Contact for consultations.
Read MoreBest IVF Centre in Meerut
New World Fertility Centre in Meerut provides expert IVF treatments with personalized care. We’re dedicated to helping couples achieve parenthood. Contact us to start your fertility journey today!
Read MoreBest IVF Centre in Amritsar
New World Fertility Centre in Delhi offers expert IVF care with advanced technology and personalized treatment. Enjoy high success rates, affordable pricing, and comprehensive support. Contact us!
Read MoreBest IVF Centre in Mathura
Searching for IVF in Mathura? New World Fertility Centre in Delhi provides expert care, advanced technology, and high success rates. Contact us!
Read MoreBest IVF Centre in Bhopal | New World Fertility
New World Fertility Centre in Delhi offers best IVF services in Bhopal, featuring expert care, advanced technology, and personalized treatment plans. For high success rates and supportive care, visit their website for more information.
Read MoreBest IVF Centre in North Delhi | New World Fertility
New World Fertility Centre is the best IVF centre in North Delhi, providing expert care and high success rates for couples seeking fertility treatments.
Read MoreBest IVF Centre in Ajmer
New World Fertility Centre in Ajmer offers advanced IVF treatments, experienced specialists, and personalized care. Achieve your dream of parenthood with our high success rates and comprehensive fertility services. Contact us Now.
Read MoreBest IVF Centre in Chandigarh
New World Fertility Centre in Chandigarh is a best IVF center, offering expert care and advanced treatments like IVF, IUI, and egg freezing to help couples achieve their dream of parenthood.
Read MoreBest IVF Centre in Surat
Choose New World Fertility Centre in Surat for top-notch IVF. We offer advanced treatments and expert care to help you achieve your dream of parenthood. Contact us to start your journey!
Read MoreBest IVF Centre in Haryana
New World Fertility Centre in Delhi is the best IVF centre for Haryana, providing IVF, IUI, and embryo freezing with expert care and high success rates. Contact them to begin your journey to parenthood!
Read MoreBest IVF Centre in Ghaziabad
New World Fertility Centre is the best IVF centre near Ghaziabad, known for expert care, advanced technology, and high success rates. We offer personalized treatment and support to guide you on your journey to parenthood. Contact us today!
Read MoreBest IVF Centre in Jaipur
For best IVF centre, consider New World Fertility Centre in Delhi. With advanced technology, expert specialists, and high success rates, it’s a premier choice for effective fertility treatments. Call us!
Read MoreBest IVF Centre in Delhi | New World Fertility
Infertility is a challenge faced by many couples, but thanks to advancements in medical science, treatments like In Vitro Fertilization (IVF) offer hope. If you’re looking for the best IVF centre in Delhi, it’s crucial to choose one that combines expertise, technology, and compassion. Let us guide you through the essential aspects of finding the right clinic and why New World Fertility stands out.
Read MoreBest IVF Center in Delhi | New World Fertility
Looking for the Best IVF Center in Delhi? At New World Fertility, we offer advanced fertility treatments with high success rates. Our expert specialists use cutting-edge technology to help you achieve parenthood. From IVF and ICSI to fertility preservation, we provide personalized care tailored to your needs. With compassionate support and ethical practices, we make your IVF journey smooth. Book a consultation today and take the first step toward your dream family!
Read MoreCauses of Infertility | new world fertility
Explore causes like ovulation issues, tubal blockages, and sperm problems. Genetic factors and age also influence fertility. Seek expert care at New World Fertility Centre in Delhi for personalized solutions.
Read MoreUnderstanding the Risks of IVF
IVF has risks such as OHSS, multiple pregnancies, and miscarriage. At New World Fertility Centre, we manage these with expert care and support. Contact us for more information.
Read MoreWhy choose IVF if you have unexplained infertility?
For unexplained infertility, IVF at New World Fertility Centre offers advanced techniques and personalized care to boost conception chances, even when the cause is unknown.
Read Moreआईवीऍफ़ फेल होने के क्या कारण हैं?
आईवीऍफ़ फेल होने के कारणों में एंब्रियो की गुणवत्ता, अंडाणु और शुक्राणु की समस्याएँ, गर्भाशय की समस्याएँ, हॉर्मोनल असंतुलन, और उम्र शामिल हैं। लाइफस्टाइल और तनाव भी असर डाल सकते हैं। सही सलाह और उपचार से सफलता की संभावना बढ़ सकती है।
Read MoreMultiple IVF Failures | New World Fertility
Struggling with multiple IVF failures? Causes can include embryo quality, age, and lifestyle. At New World Fertility Centre, we offer expert support and advanced testing to improve your chances. Consult Dr. Apoorva Mishra for tailored solutions.
Read MoreBest IVF Centre in Jabalpur | New World Fertility
Discover top IVF treatment for Jabalpur residents at New World Fertility Centre in Delhi. Offering high success rates, advanced facilities, and personalized care. Start your parenthood journey with our expert team.
Read MoreBest IVF Centre in Dwarka
New World Fertility Centre in Dwarka, Delhi, offers top IVF treatments with personalized care and advanced technology. Trust our experienced team to help you achieve your dream of parenthood.
Read MoreBest IVF Centre in Srinagar
Discover Srinagar's leading IVF centre, New World Fertility Centre, offering expert care in IVF, IUI, egg freezing, sperm freezing, and surrogacy services with high success rates and compassionate support.
Read MoreBest IVF Centre in Patna
New World Fertility Centre in Patna offers expert IVF, IUI, and surrogacy services with high success rates and affordable pricing. Contact us to begin your journey to parenthood!
Read MoreBest IVF Centre in Firozabad
New World Fertility Centre in Firozabad offers expert IVF care, advanced technology, and high success rates, with a range of services and personalized support throughout your fertility journey.
Read MorePermanent Pregnancy Sterilization in Delhi in 2025
Permanent sterilization offers a lasting contraception solution with high effectiveness. Consult our Delhi centre for expert care and personalized advice.
Read MoreFrom Hope to Motherhood: Celebrating Fertility Journeys This Mother’s Day
This Mother’s Day, we celebrate the incredible journey to motherhood, whether through IVF, ICSI, or other fertility treatments. At New World Fertility, we understand the emotional and physical challenges of the fertility journey and offer expert care every step of the way. From inspiring success stories to personalized treatments, we are here to help turn your dream of parenthood into a reality. Celebrate your progress and the hope of motherhood—no matter where you are in your journey!
Read MoreAssisted Hatching in IVF: Benefits, Process, Success Rates & Who Needs It?
Assisted hatching is an advanced IVF technique that enhances embryo implantation by creating a small opening in the zona pellucida. It benefits women over 35, those with failed IVF cycles, and frozen embryos. At New World Fertility, the Best IVF Center in Delhi, we use laser-assisted hatching for precision and safety. This method improves IVF success rates, especially in select patients. Contact New World Fertility to learn if assisted hatching is right for you and boost your chances of a successful pregnancy!
Read MoreHow to Procure Vaginal Thrush?
Vaginal thrush, a yeast infection, causes itching and discharge. It’s treatable with antifungal meds and can be prevented with good hygiene. Consult a doctor if symptoms persist.
Read MoreWhy Altruistic Surrogacy in India is a Practicable option for Foreign Couples?
Altruistic surrogacy in India is affordable and ethical for foreign couples, with quality care provided by centers like New World Fertility Centre in Delhi.
Read MoreICSI Treatment in Delhi: Process, Cost & Success Rate
ICSI (Intracytoplasmic Sperm Injection) is an advanced assisted reproductive technology (ART) used in IVF treatments. It is recommended for couples facing male infertility due to low sperm count, poor sperm motility, or abnormal sperm shape. In this procedure, a single healthy sperm is directly injected into an egg to increase the chances of fertilization.
Read MoreCan a PCOS Female get Pregnant? New World Fertility
Women with PCOS can get pregnant, though it may be more challenging due to irregular ovulation. Treatments like lifestyle changes, medications (Clomid, Metformin), and IVF can improve fertility.
Read MoreWhat is HSG (Hysterosalpingography) Test? | New World Fertility
The HSG test checks the uterus and fallopian tubes using X-rays and dye to find blockages or abnormalities. It takes 15-30 minutes and may cause mild cramping. Results help diagnose fertility issues.
Read MoreStep-by-Step IVF: Understanding the Fertility Journey | New World Fertility
In vitro fertilization (IVF) has brought hope to millions of couples struggling with infertility. It’s a journey that may seem complex and daunting at first, but understanding the steps involved can provide clarity and confidence. In this guide, we’ll break down the IVF process into simple, easy-to-follow steps, ensuring you feel informed every step of the way.
Read MoreAltruistic Surrogacy in India | Best Altruistic Surrogacy Centre in Delhi
Altruistic surrogacy is a surrogacy arrangement where the surrogate mother does not receive monetary rewards apart from reimbursement for medical and pregnancy-related costs. This ethical and humanitarian approach to surrogacy is legally permitted in India and is often chosen for its moral focus and affordability.
Read MoreSperm Cramps in Men: Causes, Prevention, and When to Seek Help
Sperm cramps in men can cause discomfort after ejaculation, often due to conditions like prostatitis, pelvic floor tension, epididymitis, or nerve irritation. While occasional mild pain may not be alarming, persistent or severe discomfort requires medical attention. Preventive measures like staying hydrated, exercising pelvic floor, and managing stress can help. Treatments vary from antibiotics to lifestyle changes. If you experience ongoing sperm cramps, consult a specialist at New World Fertility for expert guidance.
Read MoreUterine Fibroids (बच्चेदानी में गांठ): लक्षण, जाँच और सर्वश्रेष्ठ इलाज
बच्चेदानी में गांठ (Uterine Fibroids) महिलाओं में एक आम समस्या है, जो मासिक धर्म असामान्यता, दर्द और प्रजनन समस्याओं का कारण बन सकती है। यह हार्मोनल असंतुलन, आनुवंशिकी या मोटापे के कारण हो सकती है। लक्षणों में पेट दर्द, अधिक रक्तस्राव, बार-बार पेशाब आना आदि शामिल हैं। अल्ट्रासाउंड और MRI से इसकी जाँच होती है। इलाज में दवाएं, सर्जरी और लेजर तकनीकें शामिल हैं। सही समय पर इलाज से इसे नियंत्रित किया जा सकता है।
Read MoreBest IUI Centre in Kirti Nagar: Cost, Success Rates in 2025
Struggling to conceive? IUI (Intrauterine Insemination) is a simple, affordable, and effective fertility treatment. At New World Fertility, we offer personalized IUI care with high success rates in Kirti Nagar. Our expert fertility specialists use advanced techniques to improve your chances of pregnancy. Learn about IUI costs, step-by-step process, and success tips. Take the first step toward parenthood today! Call now to book your consultation.
Read MoreBest IVF Centre in Shastri Nagar: Your Trusted Partner in the Journey to Parenthood
New World Fertility, the best IVF centre in Shastri Nagar, is your trusted partner in the journey to parenthood. We offer cutting-edge fertility treatments like IVF, IUI, ICSI, and donor programs backed by expert doctors and compassionate care. Our center is equipped with the latest reproductive technology, ensuring high success rates and ethical practices. Located conveniently in Delhi, we provide personalized treatment plans, transparent pricing, and emotional support to help couples fulfill their dream of having a baby. Book your consultation today and take the first step toward parenthood.
Read MoreBest IVF Centre in Inder Lok: New World Fertility’s Expert Care Close to Home
Looking for the best IVF centre in Inder Lok? New World Fertility offers expert care, advanced IVF technology, and high success rates. From IVF and IUI to donor programs and male infertility treatments, we provide ethical, transparent, and personalized care close to your home. Conveniently located near Inder Lok metro station, our clinic is easily accessible from Karol Bagh, Ashok Vihar, and nearby areas. With experienced fertility specialists, modern labs, and emotional support at every step, we’re committed to turning your dream into a family. Book your consultation now!
Read MoreBest IVF Centre in Shakurpur – New World Fertility’s Trusted Care
Searching for the best IVF centre in Shakurpur? New World Fertility is a trusted name in advanced reproductive care, offering personalized IVF, IUI, and donor services. With expert fertility doctors, modern labs, and high success rates, we ensure compassionate care for every couple. Located near Shakurpur and easily accessible from Keshav Puram and Pitampura, our centre provides ethical, transparent treatment and emotional support throughout your parenthood journey. Book your fertility consultation today with New World Fertility.
Read MoreBest IVF Centre in Mundka – Begin Your Parenthood Journey with New World Fertility
Looking for the Best IVF Centre in Mundka? New World Fertility offers advanced fertility treatments with high success rates and compassionate care. Our expert team specializes in IVF, IUI, ICSI, donor programs, and male infertility solutions. Conveniently located near Mundka, we provide personalized care, affordable packages, and ethical practices to support your parenthood journey. Start your treatment with trusted professionals at New World Fertility today.
Read MoreBest IVF Centre in Paschim Vihar – New World Fertility
Searching for the Best IVF Centre in Paschim Vihar? New World Fertility offers advanced fertility care, personalized IVF protocols, and exceptional success rates. Located near Paschim Vihar, our centre provides world-class technology, affordable treatment plans, and compassionate support. From IVF and ICSI to donor programs and male infertility treatment, we’re with you every step. Book your consultation today and turn your dream of parenthood into reality with New World Fertility.
Read MoreBest IUI Centre in Karol Bagh: Cost, Success Rates in 2025
Finding the best IUI centre in Karol Bagh is crucial for couples seeking effective fertility treatment. IUI (Intrauterine Insemination) is a minimally invasive procedure that enhances conception chances. The cost of IUI in Karol Bagh ranges from ₹10,000-₹20,000 per cycle, depending on medications and clinic expertise. New World Fertility offers high success rates, advanced technology, and personalized care. Learn how to choose the right clinic based on success rates, affordability, and expert guidance. Start your journey to parenthood today!
Read MoreBest IUI Centre in Punjabi Bagh: Cost, Success Rates & How to Choose the Right Clinic
Searching for the best IUI centre in Punjabi Bagh? Intrauterine Insemination (IUI) is a highly effective fertility treatment for couples facing conception challenges. At New World Fertility, we offer affordable IUI treatments, high success rates, and expert fertility specialists. Learn about IUI costs, success rates, and key factors to consider when selecting a clinic. With advanced technology and personalised care, we ensure the best chances for pregnancy. Book a consultation today!
Read MoreBest IUI Centre in Hauz Khas: Achieve Parenthood with New World Fertility
Searching for the best IUI centre in Hauz Khas? New World Fertility provides expert fertility care with high success rates, advanced technology, and affordable treatment plans. Our personalized approach ensures the best chances of conception with minimal discomfort. With a team of experienced specialists and state-of-the-art labs, we help couples achieve their dream of parenthood. Book your consultation today and take the first step toward a successful pregnancy!
Read MoreBest IUI Centre in Lajpat Nagar: Success Rates, Cost & Why Choose New World Fertility?
Searching for the best IUI centre in Lajpat Nagar? New World Fertility offers advanced IUI treatment with high success rates, expert fertility specialists, and affordable pricing. Our state-of-the-art fertility clinic provides personalized care, cutting-edge technology, and a proven track record of successful pregnancies. With a cost-effective IUI package and a compassionate team, we ensure a stress-free fertility journey. Book your consultation today and take the first step toward parenthood!
Read MoreBest IUI Centre in Okhla: Success Rates, Cost in 2025
Searching for the best IUI centre in Okhla? New World Fertility provides high success rates, advanced treatments, and affordable IUI packages to help you conceive. Our expert fertility specialists use state-of-the-art technology for precise sperm selection and ovulation tracking, ensuring optimal chances of pregnancy. With transparent pricing and compassionate care, we guide you through every step of your fertility journey. Start your parenthood journey with us today!
Read MoreBest IUI Centre in Patel Nagar: Cost, Success Rates in 2025
Struggling to conceive? IUI (Intrauterine Insemination) is a simple, effective, and affordable fertility treatment. At New World Fertility, our expert doctors provide personalized IUI care with high success rates in Patel Nagar. We offer advanced technology, transparent pricing, and compassionate support to help you achieve parenthood. Learn about IUI cost, step-by-step process, and success tips. Take the first step today! Call now for a consultation!
Read MoreBest IUI Centre in Vikaspuri: Cost, Success Rate in 2025
Struggling to conceive? Intrauterine Insemination (IUI) can boost your chances of pregnancy. Vikaspuri has top fertility centres offering expert care, advanced technology, and affordable treatment. IUI is ideal for couples with unexplained infertility, ovulation disorders, or low sperm motility. Success depends on age, sperm quality, and ovulation timing. New World Fertility provides personalized, high-success IUI treatments. Take the first step—schedule a consultation today!
Read MoreBest IUI Centre in Mayapuri: Cost, Success Rate & Choosing the Right Clinic
Struggling with infertility? Intrauterine Insemination (IUI) may be the solution. Discover the best IUI centre in Mayapuri for expert care, advanced technology, and affordable treatment options. Our team at New World Fertility provides personalized treatment to increase your chances of conception. Book a consultation today and start your journey toward parenthood.
Read MoreBest IVF Centre in Kirti Nagar: Advanced Fertility Treatments 2025
Finding the best IVF centre in Kirti Nagar is key to a successful fertility journey. New World Fertility offers cutting-edge IVF, ICSI, IUI, and egg-freezing treatments with high success rates. Our experienced specialists, advanced lab facilities, and affordable pricing make parenthood accessible. With personalized care and EMI options, we ensure a stress-free IVF experience. Book a consultation today and take the first step toward your dream of having a baby!
Read MoreBest IVF Centre in Patel Nagar 2025 with high success rates
Looking for the best IVF centre in Patel Nagar? New World Fertility offers advanced fertility treatments like IVF, ICSI, IUI, and egg freezing with high success rates. Our expert specialists, cutting-edge technology, and personalized care ensure the best chances of conception. With transparent pricing and EMI options, we make fertility treatment accessible to all. Take the first step toward parenthood—book a consultation today!
Read MoreBest IVF Centre in Vikaspuri in 2025 with Advanced Fertility Treatments
Finding the best IVF centre in Vikaspuri is crucial for a successful fertility journey. At New World Fertility, we offer advanced treatments like IVF, ICSI, and IUI, ensuring high success rates with expert care. Our state-of-the-art lab, experienced specialists, and patient-centric approach make us the preferred choice. With affordable pricing and flexible EMI plans, we help couples achieve their dream of parenthood. Schedule a consultation today and take the first step towards your baby’s future!
Read MoreBest IVF Centre in Mayapuri 2025 with Advanced Infertility Treatments
Choosing the best IVF centre in Mayapuri is essential for your parenthood journey. At New World Fertility, we offer advanced treatments like IVF, ICSI, and IUI, ensuring high success rates with expert fertility specialists. Our state-of-the-art lab, transparent pricing, and personalized care make us the top choice for fertility treatments. With affordable IVF costs and flexible EMI options, we help make your dream of having a baby a reality. Book your consultation today!
Read MoreBest IVF Centre in Karol Bagh in 2025 with higher success rates
Finding the best IVF centre in Karol Bagh is crucial for a successful fertility journey. At New World Fertility, we offer cutting-edge treatments, experienced doctors, and personalized care to maximize your chances of conception. Our advanced IVF, ICSI, IUI, and donor programs ensure high success rates at affordable costs. With state-of-the-art technology and transparent pricing, we help couples fulfill their parenthood dreams.
Read MoreBest IVF Centre in Punjabi Bagh 2025 with higher success rates
Looking for the best IVF centre in Punjabi Bagh? New World Fertility offers cutting-edge fertility treatments, experienced specialists, and personalized care to help you achieve parenthood. Our advanced lab, high success rates, and transparent pricing make us a trusted choice for IVF, ICSI, IUI, and egg freezing. With compassionate support and affordable EMI options, we ensure a stress-free fertility journey. Book a consultation today and take the first step towards your dream of having a baby!
Read MoreBest IUI Centre in Panipat: Top Clinics 2025
Struggling with infertility? Intrauterine Insemination (IUI) is a safe and effective fertility treatment for couples facing conception challenges. Finding the best IUI centre in Panipat is crucial for success. Factors like success rates, experienced specialists, and advanced technology matter. New World Fertility offers top-notch IUI services with high success rates and personalized care. Book a consultation today and take the first step toward parenthood!
Read MoreBest IUI Centre in Sonipat: Cost, Success Rates 2025
Searching for the best IUI centre in Sonipat? New World Fertility offers advanced IUI treatment with high success rates, expert fertility specialists, and affordable pricing. Our state-of-the-art facility provides personalized care, advanced sperm selection techniques, and transparent cost options. With proven patient success stories, we help couples achieve parenthood dreams. Book your IUI consultation today and take the first step towards a happy family!
Read MoreBest IUI Centre in Rohtak: Top Clinic, Cost, Success Rates & Expert Care
Searching for the best IUI centre in Rohtak? At New World Fertility, we offer advanced IUI treatment with high success rates, expert fertility specialists, and affordable pricing. Whether you’re facing unexplained infertility, PCOS, or mild male infertility, our personalized care and cutting-edge technology increase your chances of conception. Book a consultation today and take the first step toward parenthood!
Read MoreBest IUI Centre in Bahadurgarh: Cost, Success Rates 2025
Searching for the best IUI centre in Bahadurgarh? New World Fertility offers advanced IUI treatment with high success rates, expert fertility specialists, and affordable costs. Our clinic provides state-of-the-art technology, personalized care, and transparent pricing. With a patient-centric approach and proven success stories, we help couples achieve their dream of parenthood. Book your consultation today and take the first step towards a happy family!
Read MoreBest IVF Centre in Rohtak: Top Clinics, Success Rates & Cost Guide (2025)
Finding the best IVF centre in Rohtak is crucial for a successful fertility journey. New World Fertility offers advanced IVF treatments, high success rates, and expert care. With cutting-edge technology, personalized treatment plans, and affordable pricing, we ensure the best chances of parenthood. Whether you need IVF, ICSI, or donor egg IVF, we provide world-class services in Rohtak. Book a consultation today to start your journey toward a happy family!
Read MoreBest IVF Centre in Sonipat: Top Clinics, Success Rates & Cost Guide (2025)
Finding the best IVF centre in Sonipat is crucial for couples struggling with infertility. New World Fertility offers cutting-edge treatments, expert specialists, and high success rates. With personalized care, affordable pricing, and advanced technology, we ensure the best chances of parenthood. Whether you need IVF, IUI, or ICSI, our centre provides world-class fertility solutions in Sonipat. Book a consultation today!
Read MoreBest IVF Centre in Panipat: Success Rates, Cost & Expert Care (2025)
Finding the best IVF centre in Panipat is crucial for couples struggling with infertility. New World Fertility offers high success rates, affordable IVF treatments, and advanced reproductive technology. With expert fertility specialists and personalized care, we ensure the best outcomes for IVF, IUI, ICSI, and egg donation. Our transparent pricing and patient-friendly approach make parenthood dreams a reality. Book a consultation today!
Read MoreBest IVF Centre in Bahadurgarh: Success Rates, Cost & Expert Care (2025)
Finding the best IVF centre in Bahadurgarh is key to a successful fertility journey. New World Fertility offers high success rates, advanced treatments like IVF, ICSI, and IUI, and expert fertility specialists. Our affordable pricing and personalized care make parenthood dreams come true. With state-of-the-art technology and compassionate support, we provide the best fertility solutions in Bahadurgarh. Schedule a consultation today!
Read MoreBest IUI Centre in Delhi - Best IUI Specialist in Delhi 2025
Choosing the best IUI centre in Delhi is crucial for a successful pregnancy. At New World Fertility, we offer expert fertility care, high success rates, and affordable treatment plans. Our advanced IUI procedure includes ovulation tracking, sperm preparation, and a painless insemination process to maximize success. With personalized care and cutting-edge technology, we help couples achieve their dream of parenthood. Book a consultation today to start your journey toward parenthood with New World Fertility!
Read MoreBest IUI Centre in Tagore Garden- Top IUI Centre
Finding the best IUI centre in Tagore Garden, Delhi? New World Fertility provides top-notch fertility care with high success rates, advanced technology, and affordable pricing. Our expert team specializes in Intrauterine Insemination (IUI), offering personalized treatments to increase your chances of conception. We use state-of-the-art sperm selection techniques and ovulation tracking to enhance success rates. With transparent pricing and compassionate care, we make your parenthood journey smoother. Start your fertility journey today with the best IUI specialists in Delhi!
Read MoreBest IUI Centre in Rajouri Garden, Delhi: Cost, Success Rates & Expert Care
Struggling with infertility? New World Fertility, the best IUI centre in Rajouri Garden, Delhi, provides advanced Intrauterine Insemination (IUI) treatment with high success rates and affordable pricing. Our expert fertility specialists, state-of-the-art technology, and personalized care ensure the best outcomes for hopeful parents. With transparent pricing and a patient-first approach, we make your parenthood journey smooth and stress-free. Book your consultation today and take the first step towards achieving your dream of having a baby!
Read MoreBest IUI Centre in Moti Nagar, Delhi -New World Fertility
Looking for the best IUI centre in Moti Nagar, Delhi? New World Fertility offers advanced Intrauterine Insemination (IUI) treatment with high success rates and affordable pricing. Our expert fertility specialists use cutting-edge technology and personalized treatment plans to maximize your chances of conception. With transparent pricing, state-of-the-art facilities, and compassionate care, we make your fertility journey smooth and stress-free. Book a consultation today with New World Fertility and take the first step towards parenthood!
Read MoreBest IUI Centre in Tilak Nagar, Delhi – Cost, Success Rates & Expert Care
Finding the best IUI Centre in Tilak Nagar, Delhi? New World Fertility provides advanced Intrauterine Insemination (IUI) with high success rates and expert fertility specialists. Our state-of-the-art technology, affordable pricing, and personalized care make us the top choice for couples seeking fertility treatments. With a patient-first approach, transparent costs, and a proven track record, we ensure a smooth journey to parenthood. Book a consultation today at New World Fertility and take the next step towards your dream family.
Read More5 Best Ways to Improve IVF Success Rate: Expert Tips
Boost your IVF success with these 5 expert-backed strategies! Maintaining a healthy diet, managing stress, selecting the Best IVF Centre in Delhi, improving egg and sperm quality, and following your doctor’s advice can significantly enhance your chances of conception. New World Fertility, recognized as the Best IVF Centre in Tagore Garden, offers personalized care and advanced fertility treatments. Take the right steps today for a successful IVF journey with the Best IVF Doctors in Delhi at New World Fertility!
Read MorePrimary Infertility: Causes, Diagnosis & Treatment (2025)
Discover the causes, diagnosis, and best treatments for primary infertility. Learn how New World Fertility can help you achieve your dream of parenthood.
Read MoreSecondary Infertility: Causes, Diagnosis & Best Treatment Options
This blog explores secondary infertility, its causes, symptoms, and diagnosis. It also covers treatment options like IVF, IUI, medications, and lifestyle changes.
Read More2 Weeks Pregnant: Beta hCG Levels (HCG Levels) 2025
At 2 weeks pregnant, your body is preparing for conception. Learn about early pregnancy signs, HCG levels, and expert tips for a smooth journey with New World Fertility.
Read Moreआईवीएफ गर्भावस्था के बाद सुरक्षा एवं सावधानियां(IVF precautions and cautions)
आईवीएफ गर्भावस्था सामान्य गर्भावस्था से अधिक संवेदनशील होती है, इसलिए अतिरिक्त देखभाल आवश्यक होती है। डॉक्टर की सलाह, संतुलित आहार, हल्का व्यायाम और मानसिक शांति इस दौरान बेहद जरूरी हैं। संक्रमण से बचाव, दवाओं का सही सेवन और यात्रा में सावधानी भी आवश्यक है। स्वस्थ और सुरक्षित गर्भावस्था के लिए New World Fertility के विशेषज्ञों से संपर्क करें।
Read More